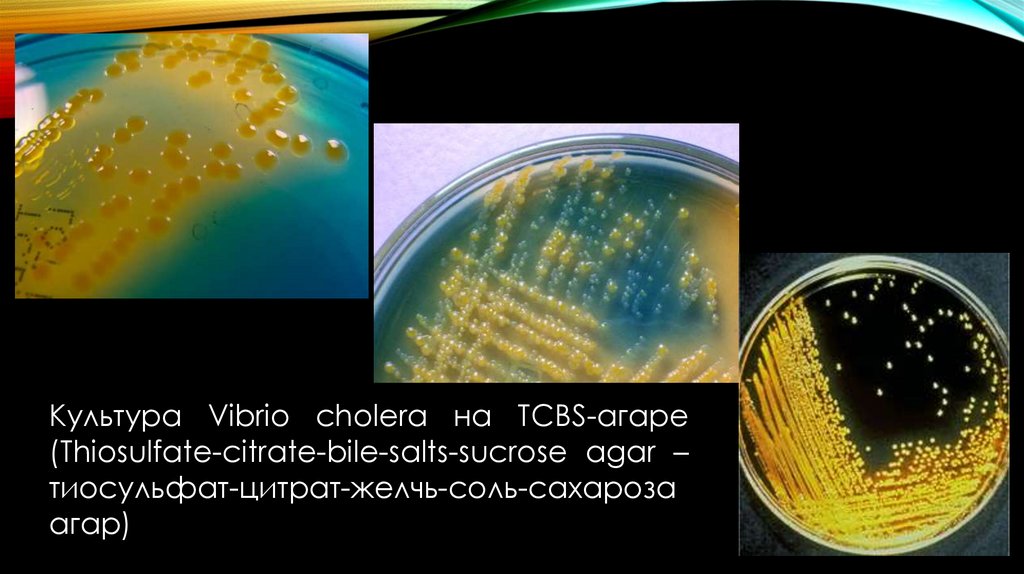

Similar presentations:
Возбудители диареегенных заболеваний: шигеллы, сальмонеллы, эшерихии, иерсинии, холера. Лекция 1
1.
Лекция 1ВОЗБУДИТЕЛИ
ДИАРЕЕГЕННЫХ
ЗАБОЛЕВАНИЙ:
ШИГЕЛЛЫ,
САЛЬМОНЕЛЛЫ,
ЭШЕРИХИИ,
ИЕРСИНИИ, ХОЛЕРА
ТулГУ, Медицинский институт,
кафедра «Санитарно-гигиенических и
профилактических дисциплин»
Д.б.н., профессор Честнова Татьяна
Викторовна
2.
ШИГЕЛЛЫ3.
ОПРЕДЕЛЕНИЕ ЗАБОЛЕВАНИЯДизентерия(бактериальная дизентерия, шигеллезы)антропонозное
инфекционное
заболевание,
характеризующееся
синдромом
общей
инфекционной
интоксикации
и
синдромом
поражения ЖКТ, преимущественно дистального
отдела толстой кишки.
4.
КЛАССИФИКАЦИЯ ШИГЕЛЛСемейство: ENTEROBACTERIACAE
Род: SHIGELLA
Вид:
-S. dysenteriae,
-S. flexneri,
-S. boydii,
-S. sonnei.
Типовой вид: S. dysenteriae
5.
МОРФОЛОГИЯШигеллы –
Гр отрицательные,
неподвижные
палочки.
Спор и капсул не
образуют
6.
ЭКОЛОГИЯ И ЭПИДЕМИОЛОГИЯПриродный резервуар – человек;
Источник инфекции – больные
острой
или
хронической
формами
заболевания
и
бактериовыделители;
Механизм передачи – фекальнооральный.(путь- алиментарный и
водный)
Контактно-бытовой
механизм
передачи играет второстепенную
роль
и
определяет
спорадическую заболеваемость.
7.
ЭПИДЕМИОЛОГИЧЕСКИЕ ОСОБЕННОСТИ• Это преимущественно детские инфекции;
• Шигеллезы распространены в странах третьего
мира;
• Их можно отнести к тяжелым заболеваниям;
• Возбудителей отличает сравнительно низкая
инфицирующая доза;
• Естественная восприимчивость людей высокая;
• Заболевание
отличает
развитие
тяжелых
осложнений, таких как, острая гипогликемия,
псевдолейкимоидная
реакция,
гемолитикоуремический синдром, перфорация кишечника.
8.
АНТИГЕННАЯ СТРУКТУРАУ шигелл выделяют:
ТЕРМОСТАБИЛЬНЫЕ О – AГ.
В основу серотипирования положены
различия в структуре О – Aг. Каждому виду
рода
соответствует
отдельная
серогруппа, обозначаемая заглавными
латинскими буквами.
Серовары и подсеровары
арабскими буквами (a,b,c).
обозначают
Серовароспецифические ( типовые) Aг
обозначают римскими цифрами (I –VI),
групповые арабскими (3,4;6;7,8)
ТЕРМОЛАБИЛЬНЫЕ КАПСУЛЬНЫЕ
К–AГ
маскирует
антигенную
структуру
и
обеспечивает
явление
инааглютинабельности.
9.
ФАКТОРЫ ПАТОГЕННОСТИSHI –Oстров
содержит
гены,
кодирующие
синтез
ЛПС у S. flexneri 1 -го
серовара, играющего
важную
роль
в
патогенезе шигеллезов.
10.
АГГЛЮТИНИРУЕТЭРИТРОЦИТЫ,
УЧАСТВУЕТ В ФОРМИРОВАНИИ
УСТОЙЧИВОСТИ К ДЕЙСТВИЮ
БАКТЕРИЦИДНЫХ
ФАКТОРОВ
СЫВОРОТКИ КРОВИ.
SHI – 1
УЧАСТВУЕТ В ФОРМИРОВАНИИ
ЦИТОПАТИЧЕСКОГО ЭФФЕКТА
В ОТНОШЕНИИ HEP2 .
(SHIGELLA ISLAND-ОСТРОВ ПАТОГЕННОСТИ ШИГЕЛЛ)
ПОМОГАЕТ РАЗЖИЖАТЬ МУЦИН В
СЛИЗИСТОЙ
КИШЕЧНИКА,
ОБЛЕГЧАЯ
КОЛОНИЗАЦИЮ
ЭПИТЕЛИЯ
УЧАСТВУЕТ В ДЕГРАДАЦИИ
КОМПОНЕНТОВ
КОМПЛЕМЕНТА
11.
ФАКТОР ПАТОГЕННОСТИ SHI-2 .Третий «остров патогенности» SHI-2
Его составляющие позволяют шигеллам
выживать
в
стрессовых
ситуациях:
сидерофоры облегчают существование
бактерий
в
условиях
с
низким
содержанием
ионов
железа,
а
невосприимчивость к колицину V позволяет
конкурировать
с
нормальной
микрофлорой кишечника.
ФАКТОР ПАТОГЕННОСТИ SHI-3.
Четвертый «остров патогенности».
Существуют
вполне
обоснованные
предположения, что приобретение SHI-3
связано с вирулентностью S.boydii.
12.
• БЕЛОК SHET – ТЕРМОЛАБИЛЬНЫЙ ЭНТЕРОТОКСИНВЫЗЫВАЕТ
ФОРМИРОВАНИЕ
ОЧАГОВ НЕКРОЗА.
ВЫЗЫВАЕТ
НАРУШЕНИЕ
ТРАНСПОРТА
ЭЛЕКТРОЛИТОВ
ВЫЗЫВАЕТ
АККУМУЛЯЦИЮ
ЖИДКОСТИ
ПОДСЛИЗИСТОЙ
В
13.
•Факторы патогенности SRL(англ. Shigella resistance locus)
-кодирует устойчивость шигелл
к антибиотикам.
УЧАСТОК
РЕЗИСТЕНТНОСТИ
ШИГЕЛЛ
14.
ПЛАЗМИДНЫЕ ФАКТОРЫ ПАТОГЕННОСТИ•Большая
часть
генов,
обеспечивающих
экспрессию
инвазивного
фенотипа,
дислоцирована в большой плазмиде.
В ее составе существует сердцевидный участок
Ipa-mxi–spa,
образующий
«остров
патогенности».
В его состав входят гены, которые кодируют:
-систему секреции III типа,
-синтез
продуктов,
обуславливающих
способность бактерий выходить за пределы
эндосом
и
проникать
в
цитоплазму
эпителиоцитов,
активировать
полиморфонуклеары,
запускать
апоптоз
макрофагов, вызывать нарушение транспорта
электоролитов,
аккумуляцию
жидкости
в
подслизистой основе.
15.
НУ ЧТО, ТОВАРИЩИ?ВСЕ ПРИСУТСТВУЮТ?
Система «чувство кворума».
Экспрессия факторов патогенности шигелл
подчиняется «чувству кворума».
Сигнальными стимулами для них выступают
условия окружающей среды. Кардинально на
экспрессию влияет температура окружающей
среды
Изменение температуры с 30 до 37°С усиливает
экспрессию более чем в 100 раз.
16.
ОБМЕН ИНФОРМАЦИЕЙ В РАМКАХ СИСТЕМЫ«ЧУВСТВО КВОРУМА» ПОСРЕДСТВОМ СИГНАЛЬНЫХ
МОЛЕКУЛ:
ПОВЫШЕНИЕ
ТЕМПЕРАТУРЫ
УСИЛЕНИЕ
ЭКСПРЕСИИ
ОПЕРОНОВ
IPA-MXI–SPA
НАПРЯМУЮ ВЛИЯЕТ
НА ПЛОТНОСТЬ
ПОПУЛЯЦИИ
ШИГЕЛЛ
ОБЕСПЕЧИВАЮТ
ЭКСПРЕССИЮ ИНВАЗИИ
В КОНЦЕ ФАЗЫ
ЛОГАРИФМИЧЕСКОГО РОСТА
ШИГЕЛЛ
ПО ЭТОЙ ПРИЧИНЕ АКТИВИРУЮЩИМ СТИМУЛОМ
ДЛЯ ШИГЕЛЛ ВЫСТУПАЕТ ПОВЫШЕНИЕ ТЕМПЕРАТУРЫ
ДО 37°С .
ПОГЛОЩЕННЫЕ ШИГЕЛЛЫ В ТЕЧЕНИЕ 15 – 60 МИНУТ
РАЗРУШАЮТ СТЕНКИ ЭНДОСОМЫ И ПРОНИКАЮТ В
ЦИТОПЛАЗМУ,
ГДЕ
НАЧИНАЮТ
БУРНО
РАЗМНОЖАТЬСЯ.
КОНТАКТ ШИГЕЛЛ С
АУТОХТОМНОЙ
ФЛОРОЙ
НА ПОВЕРХНОСТИ
КИШЕЧНИКА
ОЧЕНЬ
КОРОТКОЕ
ВРЕМЯ
БЫСТРАЯ ИНВАЗИЯ
В ЭПИТЕЛИОЦИТЫ
17.
•Экзотоксин.Несмотря на
наличие такого
извращенного способа инвазии в
эпителиоциты, самым грозным
фактором в патогенности шигелл
рассматривают
экзотоксин
(токсин Шиги).
Токсин
Шиги, более известный как веротоксин,
проявляет цитотоксическую (в т.ч. и гемолитическую)
активность, вызывает развитие микроангиопатических
нарушений, ассоциированных с геморрагическим
колитом и гемолитико – уремическим синдромом.
18.
СТРОЕНИЕ ТОКСИНА ШИГИ ТИПИЧНО ДЛЯА/В ТОКСИНОВ.
Cостоит
из
ферментативно
активного
компонента А, нековалентно связанного с
пентамером, образующим компонент В.
Внутриклеточный процессинг компонента А
катализирует
протеаза
фурин,
дислоцированная в аппарате Гольджи и
эндосомах.
Фурин
распознает
аминокислотные
последовательности компонента А токсина
Шиги.
При этом компонент А разделяется на
ферментативно-активную
часть
А1
и
фрагмент А2, при этом фрагмент А2 служит
звеном, связывающим А1 с компонентом В.
19.
• Термолабильные энтеротоксины. Помимо токсина Шиги,бактерии синтезируют термолабильные энтеротоксины.
Их
действие
проявляется
аккумуляцией
жидкости
в
подслизистой, потерей электролитов и последующей гибелью
энтероцитов.
• Факторы апоптоза. После проникновения в эпителий
кишечника
основная
часть
бактерий
оказывается
в
лимфоидных фолликулах, насыщенных макрофагами и
дендритными клетками.
Шигеллы экспрессируют инвазивный фенотип, вызывают гибель
макрофагов и дендритных клеток, преимущественно за счет
активации программы апоптоза.
Аналогичный подход бактерии используют и в отношении
полиморфонуклеаров.
20.
ФАКТОРЫ РАЗВИТИЯ МЕСТНОЙ ВОСПАЛИТЕЛЬНОЙ РЕАКЦИИШИГЕЛЛЫ
УНИЧТОЖАЮТ
ФАГОЦИТЫ И ИНДУЦИРУЮТ
РАЗВИТИЕ
МЕСТНОЙ
ВОСПАЛИТЕЛЬНОЙ РЕАКЦИИ
ЗА
СЧЕТ
ГИДРОЛИЗА
ПРЕДШЕСТВЕННИКОВ ИЛ- 1Β.
БЫСТРАЯ
ГИБЕЛЬ
МАКРОФАГОВ
ТАК
ЖЕ
СОПРОВОЖДАЕТСЯ СНИЖЕНИЕМ ЧИСЛА РЕЦЕПТОРОВ
К ИЛ-1, ЧТО НАБЛЮДАЕТСЯ В ИНФИЦИРОВАННЫХ
ТКАНЯХ КИШЕЧНИКА В ТЕЧЕНИЕ ПЕРВЫХ 4-Х ЧАСОВ
ИНФЕКЦИОННОГО ПРОЦЕССА
ЭТО ПРИВОДИТ
К
РАЗВИТИЮ
ТЯЖЕЛОГО
ВОСПАЛИТЕЛЬНОГО
ПРОЦЕССА.
ПАРАЛЛЕЛЬНО
ВЫСВОБОЖДЕНИЕ
ИЛ-18,
ИНДУКТОРА
ИФНΓ,
СПОСОБСТВУЕТ
РАЗВИТИЮ
ИММУННЫХ
РЕАКЦИЙ,
НАПРАВЛЕННЫХ
НА
УНИЧТОЖЕНИЕ БАКТЕРИЙ.
БЫСТРОЕ ВЫСВОБОЖДЕНИЕ ИЛ-1Β ПРИВОДИТ К
НАРУШЕНИЮ
ЭПИТЕЛИАЛЬНОГО СЛОЯ И
ДЕСТАБИЛИЗАЦИИ
МЕЖКЛЕТОЧНЫХ
ВЗАИМОДЕЙСТВИЙ,
ЧТО
СПОСОБСТВУЕТ
БЫСТРОМУ РАСПРОСТРАНЕНИЮ БАКТЕРИЙ, ИХ
ИНВАЗИИ В ПОДЛЕЖАЩИЕ ТКАНИ И УСИЛЕНИЮ
ВЫРАЖЕННОСТИ ВОСПАЛИТЕЛЬНОГО ОТВЕТА
21.
В ОТВЕТ НА ИНВАЗИЮ ШИГЕЛЛ ЭПИТЕЛИОЦИТЫСИНТЕЗИРУЮТ БОЛЬШИЕ КОЛИЧЕСТВА ЦИТОКИНОВ
И ХЕМОКИНОВ, НАПРИМЕР ИЛ-8. ЕГО ВЫДЕЛЕНИЕ
ЭПИТЕЛИАЛЬНЫМИ
КЛЕТКАМИ
МОЖНО
НАБЛЮДАТЬ В УЧАСТКАХ, ДОСТАТОЧНО УДАЛЕННЫХ
ОТ
МЕСТА
ПЕРВИЧНОЙ
ИНВАЗИИ
ШИГЕЛЛ,
НЕМЕДЛЕННО ПОСЛЕ СИНТЕЗА ИЛ- 1Β .
АКТИВИРОВАННЫЕ
НЕЙТРОФИЛЫ
ВЫДЕЛЯЮТ
КОМПЛЕКС
ФЕРМЕНТОВ
И
ТОКСИЧЕСКИХ
КИСЛОРОДНЫХ РАДИКАЛОВ, ЧЕМ ВНОСЯТ САМЫЙ
ВЕСОМЫЙ
ВКЛАД
В
УВЕЛИЧЕНИЕ
ОЧАГА
ВОСПАЛЕНИЯ И ПОВРЕЖДЕНИЯ ТКАНЕЙ СТЕНКИ
КИШКИ
ВЫСВОБОДИВШИЕСЯ
ЦИТОКИНЫ
СТИМУЛИРУЮТ
ВОСПАЛИТЕЛЬНУЮ
РЕАКЦИЮ, ЧТО УСУГУБЛЯЕТ НАРУШЕНИЕ
МЕЖКЛЕТОЧНЫХ ВЗАИМОДЕЙСТВИЙ
И
ОБЛЕГЧАЕТ
БАЗАЛАТЕРАЛЬНУЮ
ИНВАЗИЮ БАКТЕРИЙ В ЭПИТЕЛИОЦИТЫ
АККУМУЛЯЦИЯ
ЭТИХ
ПРОДУКТОВ
СПОСОБСТВУЕТ
НАРУШЕНИЮ
БАРЬЕРНЫХ ФУНКЦИЙ ЭПИТЕЛИЯ И
ИНДУЦИРУЕТ
ХЕМОТАКСИС
В
ПОДСЛИЗИСТУЮ
ПОЛИМОФОНУКЛЕАРНЫХ ФАГОЦИТОВ.
22.
ПАТОГЕНЕЗ И КЛИНИКАПопав в организм
человека, шигеллы
выживают в условиях
повышенной
кислотности
(в течение 2-3 часов при
рН -2,5 -3,0).
23.
Патогенез шигеллезов состоит из:Проникновения бактерий в клетки слизистой оболочки дистального
отдела кишечника.
Стул при дизентирии имеет вид «ректального плевка». Среди грозных
осложнений шигеллезов
встречаются: кишечные кровотечения,
перфорация кишечника, пери - и парапроктит, гемолитико –
уремический синдром.
Клинически синдром проявляется внезапным желудочно – кишечным
кровотечением, гематурией, олигурией и микроангиопатической
гемолитической анемией отдела подвздошной и толстой кишок.
Размножения в них и инвазии в соседние клетки, инфицирование
эпителиальных клеток приводит к их гибели и прорыву бактерий в
подлежащие ткани.
24.
Клиническиепроявления
могут
быть
достаточно
вариабельными: от бессимптомной инфекции до тяжелых
поражений с лихорадкой, ознобом, абдоминальной болью,
тенезмами и т.д. Инкубационный период – 1-7 сут.
Больные жалуются на боль в животе, понос с кровью (40%
пациентов), слизью (50% пациентов), озноб, связанный с
повышением температуры.
Первоначально стул больных обильный ( до 10-25 раз в
сутки),однако он скоро становится реже и значительно
уменьшается в
количестве, приобретая вид и запах,
напоминающий
«тертый
картофель".
Он
состоит
исключительно из крови и слизи, а в более поздний период –
с примесью гноя.
25.
ИММУНИТЕТОсновная роль в защите принадлежит
секреторным Ig A, предотвращающим
адгезию,
и
цитотоксической
антителзависимой
активности
интраэпителиальных лимфоцитов, которые
вместе с секреторными Ig A уничтожают
шигеллы.
26.
МИКРОБИОЛОГИЧЕСКАЯ ДИАГНОСТИКАВыделение
чистой
культуры, идентификация
до вида
1. Морфологические св-ва
Экспресс-методы
(ЛЮМ,
РНИФ, латекс- агглютинация)
Иммунологические
реакции (10-14 день)
1. Для диагностики
опасный инфекций
А) суммарное количество
антител (РПГА, РНГА, РТДА,
и т.д.)
особо
2.
В
случае
массового
поражения
людей
и
животных
2. Тинкториальные св-ва
3. Биохимические св-ва
4. Серологические св-ва
Для определения серовара или хемовара
Соматический
О-антиген
Н-антиген
К-антиген (антиген
вирулентности)
5. Фаготипирование
6. Антибиотикогорамма
А.
для
выбора
препаратов
при
этиотропной терапии
Б. в качестве
маркера эпид
процесса при ИСМП
Б) Иммунограмма Ig M и
IgG
27.
Определение биохимической активности энтеробактерийОпределение биохимической активности с помощью API - тестов
28.
МИКРОБИОЛОГИЧЕСКАЯ ДИАГНОСТИКАОсновные цели микробиологического анализа:
- Подтверждение клинического диагноза;
- Установление возможности бактерионосительства у
реконвалесцентов перед выпиской из стационара в
течение 3 дней после отсутствия клинических
симптомов;
- Обнаружение возбудителя у лиц с подозрением на
шигеллез;
Выявление носительства среди декретированных
групп населения;
- Обследование объектов внешней среды для выявления
путей распространения возбудителя.
29.
-Бактериологический методОсновным материалом служат испражнения.
В крови, слизи и гное возбудителей содержится
гораздо
больше,
поэтому
для
исследования
необходимо отбирать именно эти образцы. Образцы
можно собирать ректальным тампоном из прямой
кишки. При этом берется первая порция кала. При
проведении исследования в лаборатории, после
выделения
возбудителя
и
установления
принадлежности его к шигеллам
проводят его
серологическое типирование в РА
на стекле со
специфическими сыворотками.
-Кератоконъюнктивальная проба (метод Серени).
Опыт ставят на морских свинках, которым в
конъюнктивальный мешок вносят суточную культуру
шигелл.
30.
СЕРОЛОГИЧЕСКАЯ ДИАГНОСТИКАСерологические методы применяют
для
оптимизации
диагностики
шигеллезов
и
при
проведении
эпидемиологического
анализа
по
выявлению
циркуляции
шигелл
и
источников инфекции.
АТ к Aг шигелл. Материал, полученный от
больных желательно исследовать в
динамике с интервалом 7 -10 дней.
31.
СЕРОЛОГИЧЕСКАЯ ДИАГНОСТИКАДиагностически достоверным считается увеличение титров
специфических АТ в парных сыворотках в четыре раза и
более или их снижение.
При острой дизентерии РПГА выявляет АТ в 70-80% случаев
сывороток в титрах 1:400 – 1:6400. Следует помнить, что при
хронизации шигеллезов АТ в РПГА выявляют лишь у 30 - 40%
больных и в невысоких титрах (1:100 – 1:400). В подобных
случаях большее значение имеет проба Кумбса. С ее
помощью обнаруживают даже крайне низкие титры АТ у 7080% пациентов.
32.
ИММУНОФЛЮОРЕСЦЕНТНЫЕ МЕТОДЫРИФ и РНИФ применяются для обнаружения Ar шигелл
на различных объектах окружающей среды, в
пищевых продуктах, воде, испражнениях, рвотных
массах.
Иммунофлюоресцентные методы применяются для
экспресс – диагностики Ar S.sonnei, но их применение
для обнаружения Ar S. flexneri и S. flexneri биовара
Ньюкастл считают не оправданным, так как О- Ar этих
бактерий имеет антигенное сходство с
другими
энтеробактериями.
33.
ПРОФИЛАКТИКАСпецифической
существует.
профилактики
не
Неспецифическая
профилактика
заключается в соблюдении санитарно –
гигиенических правил, требований санитарно
– противоэпидемического режима.
34.
ЛЕЧЕНИЕЗа последние 20 -25 лет наблюдается постоянный рост устойчивости
шигелл к антибиотикам.
К настоящему времени можно рассматривать устойчивость шигелл к
тетрациклинам как постоянный универсальный признак для S. flexneri и
S. sonnei . Большинство изолятов S. sonnei и S. flexneri сохранили
устойчивость к эритомицину. В ходе исследований по проведению
постоянного мониторинга за динамикой изменений чувствительности
шигелл к антибиотикам, было установлено, что большинство штаммов
сохраняет чувствительность к цефалоспоринам II поколения (исключая
цефаклор) и III поколений, а так же к фторхинолонам.
В многочисленных исследованиях отмечена высокая чувствительность
шигелл к хинолонам и особенно к фторхинолонам. Поскольку лечение
шигеллезов цефалоспоринами не нашло широкого применения в
практике, именно фторхинолоны остаются основными препаратами
выбора влечении тяжелых поражений, вызванных
резистентными
шигеллами.
Поддерживающая
терапия:
Имодиум
Лоперамид,
ферменты,
витамины парентерально, пробиотики, эубиотики.
35.
ЛЕЧЕНИЕ1)Лечебное питание. Больным назначают щадящую
диету. Пища должна приниматься дробно, 4–6 раз в
сутки. В остром периоде назначается стол № 4 по
Певзнеру. Рекомендуются слизистые супы, блюда из
измельченного или протертого мяса, отварная
нежирная рыба,омлет, каши, творог.
2)Этиотропная терапия.
- длительность курса антибактериальной терапии при
среднетяжелой
форме шигеллеза, как правило, в пределах 5 дней,
тяжелой - 5-7 дней.
36.
37.
ЛЕЧЕНИЕ3) Патогенетическая терапия. С целью регидратации при легкой форме рекомендуется пероральное применение глюкозосолевых растворов (Декстроза+ Калия хлорид+
Натрия хлорид+ Натрия цитрат (регидрон);
При среднетяжелом и тяжелом течении - в/в введение солевых полиионных растворов с учетом степени обезвоживания и массы
тела больного (квартасоль, ацесоль, хлосоль,
трисоль, дисоль).
С энтеросорбирующей целью рекомендуется пероральный прием энтеросорбентов (лигнин гидролизный (полифепан) по 1
столовой ложке
3 раза в день, поливинилпирролидон низкомолекулярный медицинский по 5 г три раза в день, уголь активированный 15-20 г три
раза в сутки,
кремния диоксид коллоидный (полисорб МП), смектит диоктаэдрический (смекта) и др.).
Со спазмолитической целью для купирования спазма толстой кишки рекомендуется применение дротаверина (папаверина)
перорально по 0,04 г 3 раза в день.
С целью коррекции микробиоценоза кишечника в периоде реконвалесценции, когда купирована острая воспалительная
реакция, рекомендуется применение бифидумбактерина, бифидумбактерий бифидум+кишечных Палочек (бификол),
лактобактерий ацидофильных и др. в течение 3-4 недель.
С целью нормализации процессов пищеварения и всасывания рекомендуется применение панкреатина по 0,5 г 2-3 раза в сутки,
гемицеллюлазы+желчи компоненты+ панкреатина по 1 драже 3 раза в сут.
Клинические рекомендации ссылка.
38.
САЛЬМОНЕЛЛЫ39.
ВЫЗЫВАЕМЫЕ ЗАБОЛЕВАНИЯВ зависимости от источника инфекции, путей
передачи и особенностей патогенеза, и форм
проявления
инфекционного
процесса,
среди
заболеваний,
вызываемых
сальмонеллами,
различают:
• Брюшной тиф и паратифы (S. Typhi, S. Paratyphi);
• Сальмонеллезы (S. Typhimurium, S. Enteritidis,
S. Choleraesuis);
• Госпитальный (нозокомиальный) сальмонеллез
(внутрибольничные
полиантибиотикорезистентные
штаммы- S. Typhimutium, S. Enteritidis, S. Virchov, S.
Infants, S. Haife и др.).
40.
CЕМЕЙСТВО: ENTEROBACTERIACEAEСогласно современной классификации,
род SALMONELLA
S.Enterica
включены все сальмонеллы,
являющиеся
возбудителями
заболеваний
человека
и
теплокровных животных
S.bongori
подразделяется
на
10
сероваров и включающий
все
сальмонеллы,
изолированные
от
холоднокровных животных.
Вид S. enterica разделен на 6 подвидов, которые в свою очередь
разделены на серовары, соответствующие
прежним видовым
названиям.
Например: S. typhi -Typhi.
41.
1)БРЮШНОЙ ТИФ И ПАРАТИФЫ• Брюшной тиф – острая антропонозная системная
инфекция, вызываемая S. Typhi, характеризующаяся
общей интоксикацией организма, циклическим
течением,
с
преимущественным
поражением
лимфатического
аппарата
тонкого
кишечника,
бактериемией, лихорадкой, сыпью в виде розеол.
42.
ВОЗБУДИТЕЛИ БРЮШНОГО ТИФА ИПАРАТИФОВ
• Семейство - ENTEROBACTERIACEAE
• Род - SALMONELLA
• Вид - S. Enterica
• Подвиды - S. typhi, S. paratyphi A, S. paratyphi B
43.
МОРФОЛОГИЯ• Сальмонеллы- это подвижные грамотрицательные
палочки, размером 0,7х1,5х2-5 мкм.;
• Капсулу не образуют;
• Хорошо растут на питательных и желчесодержащих
средах;
• Обладают выраженной биохимической активностью,
по биохимическим свойствам род однороден.
44.
ЭПИДЕМИОЛОГИЯБрюшной тиф и паратифы – антропонозы.
Источником инфекции является больной или
носитель, которые выделяют возбудителя во внешнюю
среду с испражнениями, мочой и слюной.
Возбудители сальмонеллеза сохраняются длительно
почве и в воде.
45.
Механизмы передачи:-фекально-оральный,
-контактно-бытовой,
-воздушно-пылевой.
Пути передачи:
-водный,
-контактный
( непрямой)
-пищевой.
Факторы передачи: инфицированные пищевые продукты
(вода, молоко, сметана, творог, яйца мясной фарш и т.д.).
Естественная восприимчивость людей очень высока,
инфицирующая доза равняется приблизительно 1000
микробных клеток.
46.
АНТИГЕННАЯ СТРУКТУРАУ сальмонелл выделяют:
В связи
с тем, что по
биохимическим
свойствам
сальмонеллы
однотипны,
их
дифференциация внутри рода
проводится
по
антигенной
структуре.
47.
Их изучение положено в основу диагностическойантигенной схемы Кауфманна–Уайта, которой в
практической бактериологии пользуются до сих
пор, хотя она является самой старой.
В
основе
этой
классификации
лежит
подразделение сальмонелл на серогруппы:
- по общности строения О–Аг
- внутри серогруппы - на серовары
- в соответсвии с различиями в строении Н–Аг.
48.
49.
50.
51.
Термостабильные О – АгВыдерживают:
-кипячение в течение 2,5 часов
-автоклавирование при 120 гр. в течение 30 мин.
Критерием объединения в серогруппу является
общность конечного сахара, который является
3,6 – дидезоксигексозой.
О – Аг состоит из:
боковая S – цепь
R-ядро
+
сахара, выполняющие
функции рецепторов, их
обозначают цифрами
52.
Термолабильный Н – антигенразрушается при температуре 75 – 100 гр., является
двухфазным, это связано с тем, что синтез
кодируется двумя независимыми генами, работа
одного из них исключает работу другого. Поэтому в
каждой клетке может быть синтезирован только один
белок (фаза).
I фаза
Специфическая
(обозначается буквами)
II фаза
Неспецифическая
(обозначается цифрами)
53.
Сокращенная схемаантигенной структуры
бактерий тифопаратифозной группы
(сальмонеллезной)
54.
ГРУППА№
ТИП
О-АНТИГЕН
Н-АНТИГЕН
1-Я ФАЗА
А
1
S. paratyphi A
1
2
12
В
2
3
4
S. paratyphi B
S. typhi murium
S. stanley
2
*
4
*
*
5
*
*
C
17
18
19
S. paratyphi C
S. choleraesuis
S. Thompson
6
*
*
7
*
*
Vi
D
34
35
36
S. typhi
S. enteritidis
S. dublin
1
*
9
9
*
12
12
*
E
44
45
S. senfetberg
S. london
1
3
3
19
F
56
57
S.aberdeen
S.rubislaw
11
*
G
58
S.worthington
1
13
H
60
S.carrau
6
14
J
64
S. gaminara
Другие типы
65
S. kirkee
2-Я ФАЗА
а
-
b
i
d
1,2
1,2
1,2
c
c
k
1,5
1,5
1,5
d
g, m
g, p
-
g, s, t
i, v
1,6
i
r
1,2
e, n, x
23
z
1, w
24
y
1,7
16
d
e, n, x
17
b
1,2
12
*
*
vi
10
55.
Некоторыесеровары
сальмонелл
имеют
поверхностный К–Аг, который по химической
структуре
является
полимером
Nацетилгалактозоаминоуроновой кислоты.
Этот
антиген
является
рецептором
для
бактериофагов. По спектру чувствительности к
набору Vi–бактериофагов определяется фагавар
S. Typhi, который необходим для анализа вспышек
брюшного тифа с целью выявления источника
инфекции, Vi–антиген может придавать бактерии
явление О– инааглютинабельности.
56.
ФАКТОРЫ ПАТОГЕННОСТИ1. Адгезия и колонизация, факторы инвазии
2. Белок наружной мембраны - инвазин, обеспечивающий
резистентность к фагоцитозу;
3. Фермент супероксиддисмутаза –
антифагоцитарную активность сальмонелл;
обеспечивает
4. Эндотоксин – развитие лихорадки;
5. Энтеротоксин – обладает
холерным энтеротоксином.
сходной
гомологией
с
57.
ПАТОГЕНЕЗ И КЛИНИКАУ человека сальмонеллы могут вызывать две группы
заболеваний:
Антропонозные
(брюшной тиф и
паратиф А,Б,С)
Зооантропонозные
(сальмонеллезы)
В зависимости от клинических проявлений:
типичные
(стертые)
атипичные
(абортивные)
58.
По степени тяжести:Легкие
Среднетяжелые
Тяжелые
По характеру они могут быть:
циклическими
рецидивирующими
неосложненными
осложненными
Инкубационный период 9 -14 суток.
59.
Адгезиюк
клеткам
эпителия
обеспечивают
маннозочуствительные
пили 1 - го типа, 3-го и 4 –го типов.
В отличие от шигелл сальмонеллы
самостоятельно не могут проникать в
эпителиальные клетки ЖКТ
60.
ПРОНИКНОВЕНИЕ В КРОВЬпосредством
эндоцитоза
в эпителиальные
клетки ЖКТ
бактерии
мало
приспособлены к
размножению
в
эпителиальных
клетках
и проникают в
базальную
мембрану
кровоток
вызывает
развитие
местной воспалительной
реакции
и
приток
жидкости
в
очаг
воспаления.
61.
Появление диареиэнтеротоксинов.
обусловлено
выработкой
-Термолабильный–LT токсин
(сходный
с энтеротоксином
эшерихий и
холерогеном возбудителя холеры, увеличивают
содержание цАМФ.)
-Термостабильный–ST токсин
(напоминает цитотоксин
шигелл, нарушает
синтез
белков,
активизирует
образование
простогландинов.)
62.
ГЕНЕРАЛИЗАЦИЯ ПРОЦЕССАВ отличие от прочих сальмонелл
возбудители
тифа
и
паратифа,
проникнув
в
кровоток,
способны
выживать и размножаться в фагоцитах,
а после гибели последних в больших
количествах высвобождаться в кровь.
63.
ИММУНИТЕТИммунитет после перенесенного заболевания
длительный.
напряженный и
Протективность
иммунитета
обеспечивается
синергичностью
клеточного иммунитета, в котором ведущая роль принадлежит
активированным макрофагам.
Гуморальный иммунитет самостоятельно не обладает протективной
активностью, а является свидетелем инфекционного процесса. К
концу первой недели заболевания появляются антитела к О – Аг,
титры которых достигают максимального значения к разгару
заболевания, а затем исчезают. Антитела к Н – Аг появляются в
период реконвалесценции и у привитых лиц и длительно сохраняются.
У бактерионосителей брюшного тифа обнаруживаются антитела к Vi
–Аг, возникновение носительства связано с недостаточностью
макрофагов.
64.
2)САЛЬМОНЕЛЛЕЗ-острая кишечная зоонозная инфекция,
вызываемая
многочисленными
сероварами
сальмонелл,
характеризующаяся преимущественным
поражением ЖКТ и протекающая:
-чаще в виде локальной инфекции (в
форме гастроэнтерита),
-реже
в
виде
генерализованных
форм:
ТИФОПОДОБНОЙ или СЕПТИКО – ПИЕМИЧЕСКОЙ.
65.
ВОЗБУДИТЕЛИ САЛЬМОНЕЛЛЕЗА• Семейство - ENTEROBACTERIACEAE;
• Род – SALMONELLA;
• Вид - S. Enterica;
• Подвиды - S. Typhimurium, S. Enteritidis, S.
Choleraesuis.
66.
ЭКОЛОГИЯ и ЭПИДЕМИОЛОГИЯВозбудители, согласно современной классификации относятся к
подвиду enteric,вызывают заболевание как у животных, так и у человека.
В настоящее время на территории Росси доминирует в качестве
возбудителя сальмонеллеза серовар S.Enteritidis.
Основным
резервуаром
возбудителя
в
природе
являются
сельскохозяйственные животные. У животных заболевание протекает
как в форме клинически выраженной системной инфекции так и в
форме бактерионосительства, при этом животные выделяют
возбудителя с мочой, испражнениями, слюной и молоком.
Дополнительным резервуаром инфекции являются так же птицы
(водоплавающие и куры). У них происходит трансовариальная
передача возбудителя.
67.
Механизм передачи- Фекально-оральный;Заражение происходит алиментарным и водными путями.
Заражающая доза – от одного миллиона до ста миллионов
микробных клеток. (1*106 - 1*108)
Больной сальмонеллезом человек выделяет возбудителя в период
от трех дней до трех недель, иногда до года.
Основными факторами передачи являются:
Инфицированные мясо, молоко, яйца, субпродукты, особенно –
печень крупного рогатого скота и свиней, а так же вода.
Естественная восприимчивость людей к сальмонеллезам - высокая
68.
ПАТОГЕНЕЗ и КЛИНИКАЗаболевание протекает чаще в локальной форме
гастроэнтерита, ведущий симптом – диарейный.
Возникает изнуряющая диарея за счет потери
жидкости организмом, которая скапливается в
тонком кишечнике.
69.
Простагландин – это вещество, образующееся впроцессе метаболизма арахидоновой кислоты, они
относятся к эйкозаноидам.
Жирные кислоты входят в состав
которые имеются во всех тканях.
фосфолипидов,
Под действием фосфолипазы A2 происходит распад
арахидоновой кислоты, после чего она встает на
циклооксигеназный
или
липооксигеназный
пути
метаболизма.
Простагландины
являются
циклооксигеназного пути метаболизма.
продуктом
70.
Простагландин – это вещество, которое принимает активное участие вбольшинстве процессов, происходящих в нашем организме.
• Простагландин E обладает депрессорным действием, то есть
способствует снижению артериального давления, влияя на тонус сосудов.
• Простагландины активируют сократительную функцию миометрия,
способствуют повышению синтеза слизи, которая вырабатывается
бокаловидными клетками желудка.
• Подавляется образование пепсина и соляной кислоты, влияют на
реологические свойства крови, подавляя агрегацию тромбоцитов.
• Простагландин E влияет на гладкомышечные клетки трахеи и бронхов, он
способствует их расслаблению и расширению дыхательных путей,
участвуют в появлении других признаков воспаления.
• Изменение тонуса сосудов под действием простагландинов ведет к
гиперемии, а увеличение проницаемости их стенки – причина
формирования отеков.
• Простагландины, помимо всего, влияют на блуждающий нерв, вызывая
тошноту и рвоту.
71.
Лейкемоидная реакцияразличные раздражители.
возникает
в
ответ
на
В ее основе лежит повышенная восприимчивость
костного мозга. Лейкемоидные реакции у детей
возникают чаще, чем среди взрослых. В основном они
характеризуются изменениями со стороны «белой»
крови. Число лейкоцитов может достигать 50*109/л. В
норме этот показатель в 10 раз ниже.
72.
Лейкемоидные реакции — это временное состояние, при которомнаблюдаются существенные изменения содержания лейкоцитов в крови.
Такие реакции являются результатом усиленного образования и
поступления лейкоцитов, в том числе незрелых форм, в кровь, под
влиянием какого-то раздражителя.
73.
На фоне некоторых заболеваний происходитстимуляция кроветворения, преимущественно белого
ростка.
Большое количество лейкоцитов выбрасывается в
кровь, не достигая степени зрелости, в том числе
обнаруживаются и бласты. Бластных клеток не так
много, всего 1-2 %, что отличает реактивные
лейкоцитозы от лейкозов. Не страдает выработка
других элементов крови: нет анемии и снижения
уровня тромбоцитов. При устранении первопричины
происходит нормализация состава крови.
74.
1. ИНВАЗИЯ ТРАНСЦИТОЗОМЧЕРЕЗ
М-КЛЕТКИ
В
ПОДСЛИЗИСТЫЙ СЛОЙ
2.
ЗАХВАТ
САЛЬМОНЕЛЛ
МАКРОФАГАМИ
ЭНДОТОКСИН, НАКОПИВШИЙСЯ В РЕЗУЛЬТАТЕ
ГИБЕЛИ САЛЬМОНЕЛЛ, УСИЛИВАЕТ СИНТЕЗ
ПРОСТАГЛАНДИНОВ
ИЗ
АРАХИДОНОВОЙ
КИСЛОТЫ,
ВХОДЯЩЕЙ
В
СОСТАВ
ФОСФОЛИПИДОВ МЕМБРАН
3.
ПЕРЕНОС
САЛЬМОНЕЛЛ
В
ПЕЙРОВы БЛЯШКИ
ОДНОВРЕМЕННОЕ
РАЗМНОЖЕНИЕ В
ПОДСЛИЗИСТОЙ
4.
РАЗМНОЖЕНИЕ
В
МАКРОФАГАХ, ФОРМИРОВАНИЕ
ПЕРВИЧНОГО
ОЧАГА
ВОСПАЛЕНИЯ
5.
ВЫДЕЛЕНИЕ
ЭНДОТОКСИНА
И
БЕЛКОВОГО
ЭНТЕРОТОКСИНА*
*ЭНТЕРОТОКСИН У САЛЬМОНЕЛЛ СОДЕРЖИТСЯ В
ПЕРИПЛАЗМАТИЧЕСКОМ ПРОСТРАНСТВЕ
75.
3. ПОСТУПЛЕНИЕ В ПРОСВЕТКИШЕЧНИКА ЖИДКОСТИ, К,
NA, ХЛОРИДОВ
4. РАЗВИТИЕ
ДИАРЕИ И РВОТЫ
2. ПОВЫШЕНИЕ
УРОВНЯ ЦАМФ
ЭНТЕРОТОКСИН: 1.АКТИВИРУЕТ
Са-ЗАВИСИМУЮ
АДЕНИЛАТЦИКЛАЗУ
ЭПИТЕЛИАЛЬНЫХ
КЛЕТОК
КРИПТ
ТОНКОГО КИШЕЧНИКА
5. РАЗВИТИЕ ОБЕЗВОЖИВАНИЯ,
НАРАСТАНИЕ ИНТОКСИКАЦИИ
76.
ИММУНИТЕТНенапряженный,
серовароспецифический,
опосредованный секреторным Ig A, который
предотвращает
процесс
пенетрации
сальмонеллами слизистой тонкого кишечника. В
крови могут определяться антитела, которые
являются свидетелями инфекционного процесса.
77.
3)ВНУТРИБОЛЬНИЧНЫЕ(НОЗОКОМИАЛЬНЫЕ) САЛЬМОНЕЛЛЕЗЫ
Возбудителями нозокомиальных сальмонеллезов
являются полиантибиотикорезистентные штаммы:
S. Typhimurium , S.Enteritidis, S.Virchov, S. Infantis, S.
Haifa и т.д.
Госпитальные штаммы сальмонелл отличаются от
прочих сальмонелл и представляют особую
биологическую группу.
78.
ДЛЯ НИХ ХАРАКТЕРНО:наличие криптичной плазмиды с характерной
молекулярной массой;
отсутствие
типируемости
типовыми
бактериофагами;
изменение биохимических свойств.
79.
ЭПИДЕМИОЛОГИЯИсточником инфекции и основным резервуаром
возбудителей являются дети и взрослые: больные и
бактерионосители (находящиеся или поступающие в
стационар).
В эпидемический процесс вовлекаются прежде дети в
возрасте до одного года, особенно новорожденные, а так
же взрослые: пациенты хирургических стационаров и
реанимационных
отделений,
перенесших
тяжелые
обширные операции, пожилые люди, пациенты с тяжелой
самотической
патологией,
сопряженные
с
иммуносупрессией.
80.
•Основной механизм передачи инфекции – воздушно–капельный, путь - пылевой (при вдыхании воздуха,
содержащего пылевые частицы с адсорбированными
на них сальмонеллами);
Контактно – бытовой механизм - через предметы
обихода, посуду, грязные руки мед. персонала;
Фекально-оральный
продукты и воду.
механизм
–
через
пищевые
Заражающая доза – от одной одной тысячи до десяти
тысяч клеток (1*103 – 1*104)
81.
ПАТОГЕНЕЗ И КЛИНИКА• Внутрибольничный
сальмонеллез
характеризуется
длительными инкубационным периодом от 8 до 43 суток.
• Заболевания
характеризуются
необычными
симптомами.
• Проявление болезни варьирует от бессимптомного
носительства до выраженных кишечных расстройств с
развитием генерализованных форм инфекции с
септическими осложнениями.
82.
• Иммунитет не формируется;• Профилактика
осуществляется
бактериофагом;
• Для
лечения
антибиотикотерапию.
применяют
поливалентным
этиотропную
83.
ДИАГНОСТИКА:БАКТЕРИОЛОГИЧЕСКИЙ МЕТОД
Материалом для исследования могут быть: испражнения,
моча, промывные воды желудка и рвотные массы, кровь.
При брюшном тифе так же, производят забор проб из кожных
высыпаний, а при наличии специальных показаний – из желчи ,
дуоденального содержимого, СМЖ и секционного материала.
Можно исследовать остатки пищи, съеденной заболевшим,
исходные продукты и полуфабрикаты, использованные для ее
приготовления,
корма
растительного
и
животного
происхождения, смывы с различного оборудования и других
предметов, подозреваемых в качестве фактора передачи
возбудителя.
84.
При брюшном тифе и паратифах кровь исследуют длявыделения возбудителя в течение всего лихорадочного
периода и при рецидивах;
желчь и дуоденальное содержимое – в течение всего
периода заболевания и после выздоровления;
материал из розеол – в период их появления;
исследование испражнений и мочи начинают с конца
второй недели заболевания, а при других клинических
формах заболевания – с первого дня.
При необходимости делают стернальную пункцию.
85.
При обследовании на бактерионосительствоисследуют желчь испражнения и мочу. При
гастроэнтеритах
–
рвотные
массы,
промывные воды желудка и кал.
Постмортально
материалом
для
исследования могут быть кусочки желчного
пузыря, селезенки, содержимое кишечника,
мезентериальные
лимфатические
узлы,
костный мозг, кровь из сердца.
86.
87.
СЕРОЛОГИЧЕСКИЕ ИССЛЕДОВАНИЯтест
РПГА
88.
Реакция пассивной гемагглютинации - РПГА(реакция непрямой гемагглютинации - РНГА)
выявляет АТ к О–Aг
Если РА при брюшном тифе в острый период болезни
выявляет АТ к О-Aг лишь у 92% больных, к Н-Aг – у 43%, к
Vi–Aг у 50 – 70% заболевших, то при РНГА эти цифры
значительно выше. РНГА выявляет даже низкие титры
АТ. Кроме того, обнаружение Vi–АТ – диагностический
признак заболевания.
89.
В РНГА выявляют антитела сыворотки крови с помощьюантигенного эритроцитарного диагностикума, который
представляет собой эритроциты с адсорбированными на
них антигенами.
90.
Реакция непрямой (пассивной) агглютинации.Эритроциты (или частицы латекса) с адсорбированными на них
антигенами взаимодействуют с соответствующими антителами
сыворотки крови, что вызывает склеивание и выпадение
эритроцитов на дно пробирки или ячейки в виде фестончатого
осадка. При отрицательной реакции эритроциты оседают в виде
пуговки.
91.
РПГА ставят в пластиковых планшетках или впробирках
с
разведениями
сыворотки
крови
больного, к которым добавляют эритроцитарный
диагностикум.
92.
Реакция обратной непрямой гемагглютинацииИногда применяют антительный эритроцитарный диагностикум эритроциты, на которых адсорбированы антитела. Например, можно
обнаружить ботулинический токсин, добавляя к нему эритроцитарный
антительный ботулинический диагностикум (такую реакцию называют
реакцией обратной непрямой гемагглютинации (РОНГА).
93.
-РЕАКЦИЯ КУМБСА на основе РНГА.Ставят ее тех случаях, когда при проведении
РПГА АТ не обнаруживают или выявляют в
небольших количествах. Титры АТ в реакции
Кумбса на основе РНГА – в 8-16 раз выше
титров АТ, выявляемых простой РПГА . При этом
неполные антитела у больных появляются
раньше и исчезают позже, поэтому реакцию
КУМБСА можно ставить при ранней и
ретроспективной диагностике.
94.
ЭКСПРЕСС-МЕТОДДля экспресс-диагностики применят РИФ и РНИФ,
выявляющие
Aг сальмонелл. Метод применяют для
обнаружения сальмонелл в испражнениях, рвотных
массах, в объектах окружающей среды. Можно готовить
мазки – отпечатки со слизистой кишечника, взятых при
ректороманоскопии.
Этот метод несмотря на достаточную чувствительность
не
обеспечивает
достаточную
специфичность
результатов. Такие артефакты обусловлены сходством
антигенной
структуры
сальмонелл
и
некоторых
энтеробактерий.
95.
ПРОФИЛАКТИКАСпецифическая
профилактика
для предупреждения заболеваний
брюшным тифом разработано три
типа вакцин
убитая (эффективность 50 -70%),
живая аттенуированнная (из штамма
Ту21а),
проявляющая
больший
защитный
эффект,
но
дающая
большее количество осложнений,
вакцина из Vi–Aг S. typhi.
Неспецифическая
профилактика
основана
на
проведении
ветеринарно
–санитарных
мероприятий,санитарно
–
гигиенических
и
противоэпидемических
мероприятий.
96.
ЛЕЧЕНИЕСальмонеллы
отличает
способность
быстро
развивать
резистентность ко многим антибактериальным препаратам, по
данным центра по контролю за инфекционными болезнями США,
проводящих три широкомасштабных компании с пятилетними
интервалами(1970-1980 гг.,1984-1985 гг., 1989 – 1990 гг.), устойчивость
«нетифозных» сальмонелл существенно возросла, особенно за два
последних периода.
Распространение резистентных изолятов приводит к поистине
драматическим ситуациям. Например в Дании, смертность от
резистентных штаммов сальмонелл взросла в 4,8 раз.
Смертность от поражений сальмонеллами устойчивыми к
фторхинолонам возросла в 10,3 раза.
97.
Высокая химиорезистентность сальмонелл обусловленаналичием большого количества плазмидных генов
резистентности и высокой частотой обмена ими между
бактериями–донорами и бактериями–реципиентами.
R–плазмиды сальмонелл содержат большую группу
генов,
кодирующих
синтез
широкого
спектра
ферментов–инактиваторов.
У них выделены B-лактамазы широкого спектра
действия класса
А и цефалоспориназы класса С.
Установлена способность горизонтальной передачи
генов, кодирующих В-лактамазы расширенного спектра
группы SHV, от госпитальных штаммов.
98.
Росту химиорезистентностисальмонелл к β–
лактамам
так же способствует применение
оксимино β–лактамов в современном птицеводстве и
животноводстве.
В связи с вышеизложенным, антибактериальную
терапию целесообразнее назначать только после
определения чувствительности к антибиотикам
выделенных изолятов. Элиминация возбудителей в
большинстве тяжелых случаев требует применения
комбинации фторхинолонов с цефтриаксоном или
аминогликозидами.
99.
РЕЗЮМЕ ПО ЛЕЧЕНИЮ• Лечение брюшного тифа:
• Для ингибирования синтеза капсулы – карбапенемы и монобактамы;
• Затем этиотропная терапия- фторхинолоны и цефалоспорины.
• Лечение банального кишечного сальмонеллеза: пробиотики, эубиотики,
симбиотики, ферменты , витамины парентерально и только затем
этиотропная терапия.
• Лечение нокозомиальных сальмонеллезов:
• 1)Остановить диарею – имодиум лоперамид
• 2)Ферменты
• 3)Симбиотики
• 4)этиотропная антибиотикотерапия
100.
ТАКТИКА ЛЕЧЕНИЯ• 1) Щадящая диета. Не рекомендуются продукты питания, приводящие к усилению
перистальтики ЖКТ, усиливающие секрецию желчи, приводящие к бродильным
процессам в кишечнике и богатые пищевыми волокнами.
• 2) Этиотропная терапия.
• Рекомендованы стартовые антибактериальные препараты для лечения
сальмонеллеза: нифуроксазид, фуразолидон, триметоприм/сульфаметоксазол,
канамицин, гентамицин, амоксициллин/клавуланат, цефексим.
Длительность курса терапии 5 – 7 дней.
• Рекомендованы препараты резерва в терапии тяжелых и генерализованных
форм сальмонеллеза: амикацин, нетилмицин, цефотаксим, цефтриаксон,
цефперазон, цефтазидим, меропенем, тиенам, рифампицин, ципрофлоксацин,
левофлоксацин.
Длительность курса терапии 7-14 дней.
• Комбинированная антибактериальная терапия применяется для лечения больных
с тяжелым, осложненным течением (фторхинолоны и аминогликозиды;
цефалоспорины и аминогликозиды).
• Длительность курса антибактериальной терапии определяется формой и
тяжестью заболевания.
101.
ТАКТИКА ЛЕЧЕНИЯ• 3) Патогенетическая терапия.
• возмещение объема циркулирующей крови;
• уменьшение интоксикации;
• профилактика специфических осложнений (ТИШ, ОПН, отек легких, отек
мозга, ДВС-синдром);
• коррекция нарушений водно-электролитного баланса
• нормализация функционирования желудочно-кишечного тракта;
• восстановление нормальной микрофлоры кишечника.
• С целью коррекции дегидратации, гипокалиемии, гипонатриемии рекомендуются
введение солевых растворов (ацесоль, хлосоль, лактосол, квартосоль, квинтасоль,
трисоль).
• Сорбенты используются у больных сальмонеллезом любой степени тяжести и форм
заболевания. Прямое действие энтеросорбентов направлено на связывание и
элиминацию из желудочно-кишечного тракта токсичных продуктов обмена и
воспалительного процесса, опосредованное действие обусловлено предотвращением
или ослаблением клинических проявлении эндотоксикоза, токсико-аллергических
реакций, диарейного синдрома. Длительность применения в среднем 3-5 дней при
легких и среднетяжелых формах заболевания, до 10-14 дней при тяжелых формах
заболевания.
102.
ТАКТИКА ЛЕЧЕНИЯ• Спазмолитики рекомендованы в качестве вспомогательной терапии при
спазмах гладкой мускулатуры желудочно-кишечного тракта.
• Пробиотики (бифидобактерии, лактобактерии, сахаромицеты и др.)
оказывают антимикробное действие, обусловленное антагонистическим
эффектом в отношении патогенных и условно-патогенных микроорганизмов,
обладают цито- и энтеротоксинным действием, повышают ферментативную
функцию кишечника. Курс лечения 10 -28 дней.
• Ферменты (препараты панкреатина, комбинированные препараты) в качестве
средств заместительной терапии при недостаточной секреции желудочных и
кишечных желез, поджелудочной железы.
• Рекомендованы Противорвотные средства –блокатор дофаминовых
рецепторов центральный.
• Клинические рекомендации ссылка.
103.
ЭШЕРИХИИ104.
История рода Escherichia ведет свое начало с 1885 г., когдамолодой педиатр Теодор Эрлих, выделил в кишечнике
новорожденных самые разнообразные бактерии. Одну из
них, встречающуюся чаще всего он назвал Bacterium coli
commune (лат. Кишечная палочка, присутствующая у всех).
Несмотря на свою повсеместную распространенность и
очевидную безвредность, вплоть до начала ХХ века ее
нередко рассматривали как возбудителя брюшного тифа,
так как ее обнаруживали в материале от
больных
брюшным тифом. С 1937 г., когда после организации
семейства Enterobacteriaceae, бактерии вошли в его
состав. С 1958 г. род Echerichia является типовым родом
семейства, а E. Coli (кишечная палочка) – типовым видом
рода.
105.
КЛАССИФИКАЦИЯВ настоящее время классификация выглядит следующим
образом:
Семейство : Enterobacteriaceae
Род : Echerichia
Вид: E. Coli; E. blatte; E. hermanii; E.vulneri;
E. fergusonii; E. albertii
НАИБОЛЬШЕЕ МЕДИЦИНСКОЕ
ЗНАЧЕНИЕ ИМЕЕТ E. COLI
106.
Условнопатогенныекишечные палочки вызывают
парентеральные эшерихиозы
Е. coli
Диареегенные кишечные
палочки
Энтеропатогенные кишечные палочки (ЭПКП)
Энетероинвазивные кишечные палочки (ЭИКП)
Энтеротоксигенные кишечные палочки (ЭТКП)
Энтероагрегативные кишеные палочки (ЭАКП)
Энтерогеморагические кишечные палочки (ЭГКП)
107.
МОРФОЛОГИЯ• E. Coli представлены прямыми грамотрицательными
палочками, размером с 0,4:0,6х2,0:6,0 мкм;
• подвижные за счет перитрихиально расположенных
жгутиков;
• Для некоторых характерно наличие микрокапсулы,
построенной из гомополимера сиаловой кислоты, такие
штаммы обозначаются как К+
108.
ЭКОЛОГИЯ И ЭПИДЕМИОЛОГИЯЕстественный биотоп эшерихий - дистальный отдел
кишечника
теплокровных.
Бактерии
относятся
к
комменсалам нормальной флоры. У человека в среднем
она составляет 1% микробной массы испражнений . В
организм хозяина постоянно поступают новые серо – и
биовары E. Coli преимущественно:
-Фекально-оральный механизм передачи ( пищевым и
водным путем)
-Контактно-бытовой механизм передачи (контактным
непрямым путем).
109.
Она достаточно устойчива вне организма хозяина, наосновании чего ее рассматривают как санитарнопоказательный микроорганизм.
В почве и воде она сохраняется до 1-1,5 мес, в
испражнениях – до 25 суток, на пищевых продуктах – от
нескольких дней до нескольких недель, намного дольше в
мясном фарше, молоке, овощных салатах, где при
температуре 18 гр. они способны размножаться. При
нагревании они быстро погибают: при 60 гр.- в течение 10
мин., при кипячении – мгновенно
110.
Длительное время широкое носительство E. Coliслужило неким «сертификатом безвредности»
бактерий. Тем не менее с начала ХХ века стали
появляться сообщения об обнаружении при
различных эпизоотиях у молодняка различных
животных. Эти заболевания получили название
колибациллезов по одному из ранних названий
бактерии Bacillus coli.
В
настоящее
время
они
известны
как
колибактериозы. Поражения человека E. Coli,
называют эшерихиозами. У кишечной палочки
существует
способность
вызывать
самые
разнообразные.
111.
В СООТВЕТСТВИИ С ЭКОЛОГИЕЙБАКТЕРИЙ
И
ИХ
АНТИГЕННОЙ
СТРУКТУРОЙ ВЫДЕЛЯЮТ СЕРОВАРЫ :
непатогенные
патогенные
(резидентные) (диареегенные)
E. Coli
E. Coli
возбудители
внекишечных
поражений
112.
Основной механизм передачи E. Coli :-фекально - оральный
Пути передачи E. Coli :
-пищевой,
-водный,
-контактно – бытовой.
При передаче патогенных сероваров между людьми главное
значение имеют больные лица и бактерионосители. Так как
многие животные являются природными хозяевами E. Coli, от них
бакте6рии могут попадать в различные пищевые продукты, а
оттуда – в организм человека. Наиболее драматично это
обстоятельство проявляется в виде вспышек геморрагического
колита с гемолитико – уремическим синдромом, вызванных
энтерогеморрагической E. Coli О157:Н7
113.
E. Coli О157:Н7 Этот серовар входит в состав кишечнойфлоры КРС, и при нарушении правил забоя
и
разделке туш КРС может попасть в мясо.
При неправильной термической обработке мясных
продуктов, особенно при приготовлении гамбургеров
или бифштексов «с кровью», бактерии выживают в них,
а затем попадают в организм человека.
114.
В последнее десятилетие E. Coliстала распространенным
нозокомиальным патогенном. В большинстве случаев заражение
происходит при
инвазивных диагностических процедурах,
хирургических вмешательствах, т.е.
происходит реализация
артефициального пути передачи инфекции.
Несмотря на традиционно сложившееся представление о
«безвредности» E. Coli , именно эти представители семейства
Enterobacteriaceae
становятся достаточно частой причиной
заболеваемости и смертности пациентов с иммунодифицитами,
так и у лиц с нормальным иммунным статусом.
Заболевание регистрируется во всех странах мира, но с конца 4050 х годов ХХ века заболевания регистрировались в основном
спорадически. Но последние исследования проведенные в
Бразилии, Мексике, Африке и Азии показали, что ЭПКП в 30–40%
случаев вызывают диареегенные заболевания у детей в возрасте
до двух лет. Заболевания протекают очень тяжело, при этом
летальность может достигать 50%.
115.
АНТИГЕННАЯ СТРУКТУРААнтигенная структура E. Coli достаточно сложна, и ее
расшифровка представляет собой одну из наиболее
сложных задач серотипирования среди прочих
представителей энтеробактерий.
У E. Coli выделяют следующие антигены:
• Соматический О–Aг
• Капсульный К-Aг
• Жгутиковый Н-Aг
• Слизистый М–Aг
• Поверхностные фимбриальные F–Aг
• Общие гетерогенные и рибосомальные антигены
116.
Серологическая идентификация E. Coliоснована на
определении О-, К -, Н - Aг
и установлении на их основе
принадлежности бактерий к тому или иному серовару по
обозначению, принятому повсеместно.
В соответствии с международно утвержденными принципами
написания антигенной структуры на первом месте ставят О-, на
втором-К-, на третьем Н-Аг.
Каждая антигенная группа имеет свой номер. В соответствии с
этим E. Coli разделяют на серовары по сочетанию О- или ОК–Aг,
далее на серологические группы по сочетанию О-, К-, и Н – или
О-,Н-Aг .
Другие антигены определяют для установления факторов
патогенности E. Coli, раскрытия механизмов патогенеза и
решения эпидемиологических вопросов.
117.
118.
К-Агповерхностные
Оболочечные
(микрокапсульные)
белковые
фимбриальные
Истинные
капсульные
антигены
119.
В настоящее время выделяют80 К–Aг, обозначаемых
арабскими буквами. Некоторые антигены выполняют роль
рецепторов для бактериофагов.
Изучение К–Aг
E. Coli выявило внутривидовые связи,
например, К18-, К22-, К 100.
Кроме того, у кишечной палочки выделены антигены
сходные с антигенами бактерий, относящихся к другим
родам или иным таксономическим группам. Ранее
существовало разделение К–Aг на L-, A-, B– типы,
различающиеся по устойчивости к температуре прогрева.
120.
В настоящее время такого разделения не проводят,однако при серотипировании E. Coli по К–Aг
необходимо помнить о наличии терморезистентных
его вариантов.
К–Aг слабо защищают E. Coli от фагоцитоза и
бактериолиза.
Многие штаммы, имеющие К–Аг, проявляют
гемолитические
и
дерматонекротические
свойства. Они токсичны для мышей и наиболее
патогенны для человека.
121.
122.
О-АНТИГЕНВ настоящее время известно 173 О–Aг , представленных
липополисахаридо-протеиновым комплексом (ЛПС ). ЛПС
находится в клеточной стенке, и только отдельные участки
специфических полисахаридных боковых цепей О–Aг
обнаруживают за ее пределами.
Полисахаридная часть представляет собой антигенную
детерминанту, отвечающую за разнообразие антигенных
разновидностей.
123.
О-АНТИГЕНЛипидная часть О–Aг
выполняет роль хелппера и
определяет токсигенные свойства.
В пределах О–группы серовары E. Coli могут иметь
различный факторный состав, обозначаемый
строчными буквами. Общий фактор в пределах
группы обозначают буквой «а», дополнительные-« b»,
«c» и т.д.
124.
125.
Н-АНТИГЕН• В настоящее время выделяют 56 Н–Aг, представленных
жгутиковыми антигенами белковой природы.
• Они термолабильны и имеют факторные антигенные
субварианты.
• В одноименных ОК– и О- группах обнаруживаются
штаммы
с
разными
Н–Aг.
Это
позволяет
дифференцировать бактерии на серовары, что имеет
большое значение для эпидемиологических исследований.
126.
Н-АНТИГЕН• Серотипирование E. Coli по Н–Aг затруднено, так
как свежевыделенные штаммы малоподвижны, и
содержание в них Aг недостаточно для диагностики.
В настоящее время доступны Н–сыворотки 15
наименований.
Н–Aг
E.
Coli
отличает
серологическая обособленность (для них не
установлены антигенные связи с Н–Aг других родов
энтеробактерий)
127.
М-АНТИГЕНЯвляется общим для всех
энтеробактерий,
поэтому
типоспецифичность.
слизистых форм
не
проявляет
Он
«макскирует»
клетку
инааглютинабельность.
и
обеспечивает
128.
АНТИГЕННАЯ СТРУКТУРАО-антиген
Н-антиген
К-антиген
ЭНТЕРОТОКСИГ
ЕННЫЕ
О6, О8, О15, О20, О25, О27, О6З, 078,
О115, О128, О148, О149, О159
Н4, Н7, Н9, Н11, Н12,
Н19, Н20, Н21, Н28,
Н40
ЭНТЕРОПАТОГЕ
ННЫЕ
О18, О20 ,О26, О28, О44, О55, О86,
О111, О119, О124, О125, О126, О127,
О128, О142, О151, О158, О159
Н2, Н6, Н7, НИ, Н12,
Н14, Н18, Н21, Н27,
Н34
ЭНТЕРОИНВАЗИ
ВНЫЕ
О28, О112, О124, О136, О143, О144,
О152, О164, О167
ЭНТЕРОГЕМОРР
АГИЧЕСКИЕ
О26, 055, О111, О125, О128, О157
ИНФ.
МОЧЕВЫВОДЯ
ЩИХ ПУТЕЙ
О1, О4, О6, О16, О18
Kl, К2, К5, К12,
К13
БАКТЕРИЕМИИ
O1, О2, Об, О22, О75,О78
Kl, К2, К5, К12,
К15, К23
МЕНИНГИТЫ
О2, О6, О7, О16, О18ас, О83
К1
Н6, Н7, Н8, Н11
129.
ОСОБЕННОСТИ ПАТОГЕНЕЗА УСЛОВНОПАТОГЕННЫХ E. COLI• Условно-патогенные E. coli способны вызывать
эндогенные гнойно-воспалительные процессы
различной
локализации,
называемые
парентеральными эшерихиозами.
• Парентеральный эшерихиоз может протекать в
виде сепсиса, нагноения ран, вторичной
пневмонии, инфекции мочевыводящих путей.
• Часто возникают на фоне иммунодефицита.
130.
ПАТОГЕНЕЗ И КЛИНИКА ДИАРЕЕГЕННЫХ E. coliДиареегенные E. Coli не являются
однородной группой. Они
подразделяются
на 4 основных категорий по наличию у них
определенных
факторов
патогенности,
их
генетической
детерминации,
особенностей
эпидемиологии,
патогенеза
и
клинических проявлений вызываемого ими заболевания.
- ЭНТЕРОПАТОГЕННЫЕ КИШЕЧНЫЕ ПАЛОЧКИ
(ЭПКП)
- ЭНТЕРОТОКСИГЕННЫЕ КИШЕЧНЫЕ ПАЛОЧКИ
(ЭТКП)
- ЭНТЕРОГЕМОРРАГИЧЕСКИЕ КИШЕЧНЫЕ ПАЛОЧКИ
(ЭГКП)
- ЭНТЕРОИНВАЗИВНЫЕ КИШЕЧНЫЕ ПАЛОЧКИ
(ЭИКП)
*Кроме них имеются еще 2 недостаточно изученных категории:
- ЭНТЕРОАГРЕГАТИВНЫЕ КИШЕЧНЫЕ ПАЛОЧКИ (ЭАКП )
-
ДИФФУЗОАДГЕЗИВНЫЕ КИШЕЧНЫЕ ПАЛОЧКИ (ДАКП)
131.
132.
1)ЭНТЕРОПАТОГЕННЫЕ КИШЕЧНЫЕПАЛОЧКИ (ЭПКП)
Возбудители этой группы - основные возбудители диарей у детей в
развивающихся странах. Поражения вызываемые ими были известны
в 40-50гг. ХХ века. Следует отметить не совсем корректную
«универсальность»
термина ЭПКП, так как это название
распространяется на все диареегенные E. Coli.
Основная группа риска – дети до двух лет. Наиболее часто
заболевания регистрируются у детей в возрасте 6-и мес. В
экспериментах
показано, что
после нейтрализации
кислого
желудочного сока, инфицирующая доза ЭПКП составляет 108 -109
микробных тел.
133.
ЭНТЕРОПАТОГЕННЫЕ КИШЕЧНЫЕПАЛОЧКИ (ЭПКП)
Вероятно
избирательная
способность
вызывать
заболевания у детей младшего возраста обусловлена
низкой по сравнению со взрослыми кислотностью желудка.
Другой возможный механизм этого феномена может быть
связан с утратой взрослыми определенных рецепторов на
эпителиоцитах кишечника. Тем не менее к настоящему
времени зарегистрированы эпидемические вспышки и у
взрослых, в том числе и людей, относящихся к группам
риска.
134.
ПАТОГЕНЕЗ ВКЛЮЧАЕТ ТРИ ЭТАПА- Адгезию на эпителии тонкого кишечника.
Факторы адгезии E. Coli: пили, инъекционные токсины,
белок Tir.
При адгезии на энтероците агрегативные
пили
устанавливают достаточно прочную «кабельную связь» с
рецепторами клетки.
Кишечные палочки формируют микроколонии на
поверхности эпителия, прочно соединенные между
собой.
135.
Е.коли.136.
137.
138.
БелокTir
после
фосфорилирования
представляет
собой
димер,
мономеры
которого имеют вид спирали и формируют
замкнутую петлю, располагающуюся между
бактерией и клеточной мембраной.
К ее проксимальным концам прикрепляются
молекулы адгезина ЭПКП - ИНТИМИНА
139.
- «Сглаживание»микроворсинок
каемчатого эпителия кишечника.
Все гены , необходимые для реализации
феномена
«прикрепления-сглаживания»,
расположены в хромосомном «острове
патогенности» LEE или как его называют
локус «сглаживания энтероцитов».
Он кодирует синтез интимина.
140.
- Повреждение цитоскелета энтероцитов.В отличие от многих возбудителей кишечных
инфекций ЭПКП не распознают какие - либо
рецепторы для специфической адгезии на
энтероцитах,
а
сами
синтезируют
их
предшественников и «имплантируют» их в
клеточную мембрану.
141.
РАЗВИТИЕ СЕКРЕТОРНОГО ОТВЕТАПовреждение микроворсинок
Само по себе спорсобно вызвать диарею за счет нарушения всасывания.
Однако очень короткий инкубационный период между заражением и
развитием диареи(несколько часов) не позволяет связать развитие последней
только с синдромом мальабсорбции.
Ген Esp C из группы SPATE
Имеет определенное значение в повреждении энтероцитов и способен
проявлять активности термолабильного энтеротоксина in vitro.
Протеин киназа С
Активизируется после адгезии ЭПКП, что приводит к повышению
проницаемости мембран энтероцитов in vitro и in vivo с потерей жидкости
и электролитов.
142.
Легкие цепи миозинаИх фосфорилирование повышает проницаемость слизистой
оболочки и приводит к нарушению межклеточных контактов.
Увеличение внутриклеточного содержания Са
Подавляет абсорбцию Na
и Cl и стимулирует секрецию Cl
энтероцитами. Таким образом, повышение уровня Са
может
стимулировать развитие секреторного ответа на адгезию ЭПКП.
Развитие местной воспалительной реакции,
выявленное в экспериментах, оказывает влияние на проницаемость
мембран энтероцитов. Поражения, вызываемые ЭПКП, причисляют к
диареям, но это не совсем верно, так как при вызываемых ими
поражениях ведущее место принадлежит функциональным
нарушениям в энтероцитах, а не развитию воспалительного ответа.
143.
2)ЭНТЕРОТОКСИГЕННЫЕ КИШЕЧНЫЕПАЛОЧКИ (ЭТКП)
Бактерии составляют вторую по времени выделения группу
диареегенных E. Coli, известную с конца 60-х гг. ХХ века.
Возбудители холероподобных заболеваний у детей и взрослых.
Наиболее часто ЭТКП вызывают заболевания у детей в странах
третьего мира, где в общей структуре острых кишечных
инфекций на их долю приходится 10 -30%.
Большинство эпидемических вспышек
вызывают штаммы –
продуценты ST.У жителей развитых стран заболевания
регистрируются в виде так называемой диареи туристов,
поэтому в эндемичных районах Латинской Америки они так же
известны под названием «месть Монтесумы»
144.
ПАТОГЕНЕЗ:Адгезию бактерий на эпителии тонкого кишечника
Она осуществляется за счет активности комплекса пилиарных и
фимбриальных факторов группы CFA (колонизационный антигенный фактор)
и CS фактор (поверхностный антиген E. Coli). Они создают преимущество
ЭТКП в колонизации эпителия перед резидентными штаммами Coli. У
значительной части ЭТКП, выделенных от человека, обнаружен новый тип
фимбрий, отличающийся значительной длиной и получивший название Longus.
Выделение токсинов.
Основные факторы патогенности ЭТКП - ST и LT, кодируемые плазмидными и
фаговыми tox- генами. По способности продуцировать токсины выделены
штаммы бактерий, продуцирующие только развитие секреторного ответа
Выделение токсинов ST или LT либо одновременно токсины обоих типов.
145.
ST ОТНОСЯТ К ГРУППЕ МЕМБРАНОПОВРЕЖДАЮЩИХТОКСИНОВ. ВЫДЕЛЯЮТ ДВА КЛАССА ТОКСИНОВ,
СУЩЕСТВЕННО РАЗЛИЧАЮЩИХСЯ ДРУГ ОТ ДРУГА:
ST1
– его действие способствует
повышению уровня цАМФ в
клетках
эпителия,
что
приводит
к
нарушению
транспорта ионов железа,
потере
электролитов
и
нарушению всасывания NaCl
с последующим выходом
жидкости из клеток.
ST2
- токсин вызывает атрофию
ворсинок каемчатого эпителия
кишечника, он не влияет на
уровень цАМФ, но нарушает
всасывание
электролитов
и
воды,а так же стимулирует
секрецию
бикарбонатов
энтероцитами и высвобождение
простогландина и серотонина
146.
• Плазмидные гены локуса, кодирующего белки, выделяемыемембраной (mxi), и локуса, кодирующего поверхностно
представляемые антигены(spa). Они участвуют
в синтезе и
секреции многих белков, обеспечивающих проявление всего
патогенного потенциала ЭИКП.
• Энтеротоксин шигелл (ShET) -2 играет в развитии диареи
ведущую роль. Его
действие напоминает активность
термостабильного токсина ЭТКП.
• Белок Sen.
Мутации гена, ответственного за синтез этого
белка способствуют снижению энтеротоксичности. Роль этого
белка до конца не изучена, но установлено, что он отвечает за
развитие водянистой диареи.
147.
МЕХАНИЗМ РАЗВИТИЯ ДИАРЕИ1)Колонизация ЭТКП на поверхности слизистой оболочки
тонкого кишечника;
2)массивный выброс энтеротоксинов;
3)нарушение водно-солевого обмена в кишечнике;
4)развитие водянистой диареи.
• Механизм развития диарейного синдрома связан с
активацией LT аденилатциклазы кишечника, а STгуанилатциклазы.
148.
3)ЭНТЕРОГЕМОРРАГИЧЕСКИЕ КИШЕЧНЫЕПАЛОЧКИ (ЭГКП)
Сравнительно
недавно
открытая
группа
микроорганизмов,
вызывающих наиболее тяжелые кишечные поражения:
•геморрагический колит- кровавый понос(при полном отсутствии
лейкоцитов в испражнениях и признаков лихорадки)
•и последующее осложнение гемолитико – уремический синдром
(микроангиит после двух случаев идиопатическая гемолитическая
анемия,
сочетающаяся
с
почечной
недостаточностью,
тромбоцитопенией и поражением ЦНС).
С начала изучения ЭГКП было установлено, что бактерии отличает
способность синтезировать мощные Vera—цитотоксины VT (Verotoxin
–англ.)
149.
VT-1 и VT-2из группы А⁄В токсинов,
активность
которых
впервые
была
установлена in vitro на клетках Vero (клетки
почек зеленых мартышек).
Бактерии могут синтезировать один или два
типа токсина одновременно, поэтому
бактерии
первоначально
получили
название
VTEC
(Vero–токсин
продуцирующие E. Coli).
150.
ПАТОГЕНЕЗХарактер первичного взаимодействия ЭГКП с энтероцитами
протекает по типу интимин – зависимой адгезии, характерной для
ЭПКП.
У ЭГКП обнаружен остров патогенности LEЕ, содержащий гены,
кодирующие
синтез интимина, сериновой протеазы espA . В
результате чего возникают характерные изменения поверхности
эпителия в виде «чаш» и « пьедесталов» с прикрепившимися
бактериями.
Происходит
сглаживание
микроворсинок
энтероцитов.
Повреждение цитоскелета и каймы эпителия кишечника приводит к
развитию диарейного синдрома.
151.
ФАКТОРЫ ВИРУЛЕНТНОСТИШигаподобный токсин
-играет ведущую роль в развитии гемоколита
-не влияет на электролитный баланс в энтероцитах
цитотоксическое
действие
связано с
подавлением
синтеза белка
развивается
местное
воспаление
возникает
отек и
повреждение
капилляров
толстого
кишечника.
152.
Энтерогемолизин-способен повреждать эритроциты in vivo
-служить в качестве инструмента высвобождения железа,
стимулирующего в качестве стимулятора роста
Система сидерофоров позволяет бактериям утилизировать
гемоглобин в качестве источника железа
Поверхностный мебранный протеин А
-синтезируется при недостатке железа в окружающей среде,
что стимулирует утилизацию гемоглобина
153.
Высококонсервативная плазмида p О157.-ее содержат все штаммы серовара О157:Н7,
-участвует в синтезе энтерогемолизина
Сериновая протеаза EspP
-участвует в повреждении цитоскелета эукариотических клеток
- участвует в развитии геморрагических поражений.
154.
4)ЭНТЕРОИНВАЗИВНЫЕ КИШЕЧНЫЕПАЛОЧКИ (ЭИКП)
• ЭИКП способны внедряться и размножаться в эпителиальных
клетках слизистой стенки толстого кишечника, вызывая их
деструкцию;
• Это обусловлено наличием у ЭИКП плазмиды размером 140 мДа,
идентичной таковой у шигелл, кодирующей синтез поверхностных
белков, опосредующих процесс инвазии в клетки слизистой
оболочки толстого кишеника;
• Следствием этого является развитие дизентериеподобного
заболевания.;
• Заражение ЭИКП происходит водным и алиментарным путями;
• Возможны вспышки ВБИ;
• С ЭИКП связан серогруппы О124, О144, О152 ( более 9 серогрупп).
155.
ЭНТЕРОАДГЕЗИВНЫЕ И ДИФФУЗНОАДГЕЗИВНЫЕКИШЕЧНЫЕ ПАЛОЧКИ*
Патогенез поражений остается плохоизученным.
Установлено, что он включает в себя два этапа:
I этап
образование толстого слоя
слизистого геля
над кишечным эпителием,
в который заключены бактерии
II этап
повреждение энтероцитов
посредством выделения
цитотоксинов.
156.
ЛАБОРАТОРНАЯ ДИАГНОСТИКАБактериологический метод
• Материалом для исследования при кишечных эшерихиозах
служат испражнения, при парентеральных – материал из
соответствующего очага (моча, отделяемое раны, кровь);
• Исследуемый
материал
(кроме
крови)
засевается
на
дифференциальные лактозосодержащие среды;
• После инкубации при 37 градусах в течение 18 часов отбираются
колонии,
агглютинирующиеся
поливалентной
ОВагглютинирующей
сывороткой,
которые
подвергаются
идентификации до вида по биохимическим тестам, с
последующим определением их серологического варианта.
157.
ПРОФИЛАКТИКА• Специфическая профилактика: не разработана;
• Неспецифическая профилактика: Сводится к
соблюдение санитарно-гигиенических правил,
санитарному
контролю
за
источниками
водоснабжения,
пищевыми
предприятиями,
продуктами питания.
158.
ЛЕЧЕНИЕ• Этиотропная терапия – инфузионная;
• Лечение и профилактика осложнений –
антибиотики при кровотечениях.
159.
ЛЕЧЕНИЕ.• 1) Щадящая диета. В остром периоде болезни больным рекомендуют щадящую
терапию (стол № 4, при нормализации стула — № 2, в период реконвалесценции — №
13).
В лёгких случаях заболевания достаточно назначения оральной регидратационной
терапии (регидрон и другие растворы, количество которых должно в 1,5 раза превышать
потери воды с испражнениями). Показаны ферменты (панзинорм-форте, мезимфорте), энтеросорбенты (полисорб, энтеросгель, энтеродез в течение 1–3 дней).
При лёгком течении болезни целесообразно использование кишечных антисептиков
(интетрикс по две капсулы три раза в день, энтерол по две капсулы два раза в день) в
течение 5–7 дней. Лёгкие и стёртые формы эшерихиозов не требуют назначения
антибиотиков.
2) Этиотропная терапия. при среднетяжёлых формах используют один из следующих
препаратов: ко-тримоксазол по две таблетки два раза в день или препараты
фторхинолонового ряда (ципрофлоксацин по 500 мг два раза в сутки перорально,
пефлоксацин по 400 мг два раза в сутки, офлоксацин по 200 мг два раза в сутки),
длительность терапии 5–7 дней.
В тяжёлых случаях фторхинолоны применяют вместе с цефалоспоринами 2-го
(цефуроксим по 750 мг четыре раза в сутки внутривенно или внутримышечно;
цефаклор по 750 мг три раза в сутки внутримышечно); и 3-го поколения (цефтриаксон
1,0 г один раз в сутки внутривенно; цефоперазон по 1,0 г два раза в сутки внутривенно
или внутримышечно; цефтазидим по 2,0 г два раза в сутки внутривенно или
внутримышечно).
160.
ЛЕЧЕНИЕ.• 3)Патогенетическая терапия.
• Проводят регидратационную терапию внутривенно кристаллоидными
растворами (хлосоль, ацесоль и пр.)
• После приёма антибактериальных препаратов при продолжающейся диарее
используют эубиотики для коррекции дисбактериозов (бифидумбактерин
форте, хилак-форте и др.) в течение 7–10 дней.
• Клинические рекомендации ссылка
http://www.minzdravkk.ru/pages/bankdocs_old/iformetod_materials/letter_esherik
hoz/
161.
ИЕРСИНИИ162.
163.
КЛАССИФИКАЦИЯСЕМЕЙСТВО: ENTROBACTERIACEAE
РОД: YERSINIA
ВИД:
Y. pestis
Y. enterocolitica
Y. pstudotuberculosis
Y. kristensenii
Y. intermedia
Y. frederikseni
164.
МОРФОЛОГИЯИ
КУЛЬТУРАЛЬНЫЕ
СВОЙСТВА ИЕРСИНИЙ
Иерсинии
концами.
–
полиморфные
палочки
с
закругленными
Все виды подвижны, кроме Y.pestis – возбудителя чумы.
Подвижность выражена после выращивания при t ниже
30°С; при t 37°С иерсинии не подвижны.
Размер и полиморфизм зависит от возраста культуры,
температуры и питательных сред для выращивания.
Некоторые виды могут продуцировать капсульное вещество,
а Y.pestis образует капсулу.
165.
При низких температурах капсульного веществаобразуется больше. Температура оптимума роста
иерсиний составляет 20 – 30 °С; нижняя граница - 02°С , верхняя граница - 39°С; оптимум рН - 5,8 –9,6.
Рост бактерий при t 10 - 12°С сопровождается
замедлением лаг – фазы, что позволяет применять
низкотемпературное культивирование (при 4°С).
• Иерсинии не отличаются биохимической инертностью.
166.
КИШЕЧНЫЙ ИЕРСИНИОЗКишечный
иерсиниоз
–
это
инфекционное
заболевание с поражением тонкого и толстого
кишечника
и
развитием
мезентериального
лимфаденита.
Возбудитель кишечного иерсиниоза – Y. enterocolitica.
167.
МОРФОЛОГИЯ И ФИЗИОЛОГИЯ• Грамотрицательные палочки, размером 1,8:2,7х0,7:0,9
мкм;
• Подвижные;
• Капсулу не образуют;
• Хорошо растут на обычных питательных средах;
• Оптимум роста при 22-28 градусах по Цельсию;
• Обладают выраженной биохимической активностью.
168.
ЭКОЛОГИЯ ВОЗБУДИТЕЛЯ• Температурный
фактор
определяет
изменчивость
бактерий, устойчивость во внешней среде, размеры
клеток, темп размножения, скорость метаболических
процессов
и даже служит фактором выбора
альтернативных
процессов
обмена
веществ,
регулирующих синтез ферментов.
Все иерсинии могут образовывать:
• гладкие (S-формы),
• шероховатые (R –формы)
• переходные (S-R формы).
169.
ЭПИДЕМИОЛОГИЯКишечный иерсиниоз выявляется во всех странах, возникает в виде
групповых, семейных, внутрибольничных вспышек.
• Резервуар инфекции – почва, вода, инфицированные через них
растения, человек, крупный рогатый скот, свиньи, собаки, кошки,
птицы;
• Источник инфекции – человек, крупный рогатый скот, свиньи,
собаки, кошки, птицы;
• Механизм передачи – фекально - оральный (путь- алиментарный
и водный).
В отличии от Y. pseudotuberculosis, Y. enterocolitica может
передаваться от человека к человеку, являясь даже причиной
внутрибольничной инфекции.
170.
Вприроде
передаются
грызунами.
Способны длительно сохраняться и даже
накапливаться при низких температурах,
например, в овощехранилищах.
Способны
вызывать
заболевания
у
сельскохозяйственных животных. Человеку
передаются
преимущественно
с
пищевыми продуктами от животных, а
также растительного происхождения.
171.
АНТИГЕННАЯ СТРУКТУРАУ Y. Enterocolitica выделяют соматический О-,
жгутиковый Н– и Aг вирулентности (Vi-Aг и W-Aг),
расположенный на наружной мембране.
Бактерии серогруппы О-10 имеют фимбрильный
Aг,
обозначаемый
как
К1.
Традиционно
серотипирование
Aг
Y.
Enterocolitica
осуществляется по общей схеме
172.
Факторы патогенностиВозбудители кишечного иерсиниоза имеют:
-адгезины и инвазины;
-низкомолекулярные
протеины
бактерицидные факторы);
-Термостабильный
энтеротоксин
таковому у ЭТКП);
-Часть
факторов
контролируется
вирулентности.
(ингибируют
(гомологичен
плазмидами
173.
ПАТОГЕНЕЗ1)Инвазия трансцитозом через М-клетки слизистой оболочки
подвздошной кишки;
2)Внедрение
в
лимфатические
образования,
затем
в
мезентериальные лимфоузлы, где вызывает развитие аденита;
3)Действие
цитотоксина
и
энтеротоксина
вызывает
воспалительный процесс в стенке кишечника и развитие диареи.
*4)При прорыве лимфатического барьера кишечника развивается
бактериемия,
следствием
которой
является
развитие
генерализованной формы инфекции с поражением селезенки,
развитием полиаденита, полиартрита, менингита, с аллергизацией
организма. У иммунодефицитных лиц может развиться сепсис.
174.
КЛИНИКА• Инкубационный период составляет в среднем 37 суток.
• Начало острое: с лихорадкой, интоксикацией,
болями в животе, расстройством стула,
появлением сыпи на коже.
• Различают гастроинтестинальную,
абдоминальную, генерализованную и вторичноочаговую формы болезни.
• Болезнь может протекать хронически до 1,5-2
лет.
175.
ЛАБОРАТОРНАЯ ДИАГНОСТИКАПри бактериологической диагностике кишечного иерсиниоза и
псевдотуберкулеза в связи с накоплением возбудителя при низких
температурах (в отличии от большинства других микроорганизмов)
материал
предварительно
забирают
в
забуференный
физиологический раствор и сохраняют в холодильнике с
периодическими высевами на среды Эндо, Плоскирева, Серова.
Подозрительные колонии пересевают для получения чистых
культур,
изучают
их
по
биохимическим
свойствам
и
идентифицируют в РА с диагностическими сыворотками.
176.
Палочка Yersinia enterocolitica в культуреПалочка Yersinia enterocolitica в чистой культуре
177.
Длясерологической
диагностики
используют
РА
и
РНГА
(на
псевдотуберкулез - с I сероваром, на
иерсиниоз - с сероварами О3 и О9)
с исследованием взятых в динамике
инфекционного процесса парных
сывороток.
178.
ПРОФИЛАКТИКА• Специфическая профилактика - не разработана;
• Неспецифическая профилактика – включает постоянный
контроль
за
водоснабжением,
технологическим
режимом обработки и хранения пищевых продуктов,
борьбу с грызунами.
ЛЕЧЕНИЕ
Этиотропная антибиотикотерапия
179.
ЛЕЧЕНИЕ.• Этиотропная терапия.
• При лечении больных в условиях поликлиники целесообразно назначать один из нижеперечисленных
антибиотиков:
• ципрофлоксацин внутрь 500 мг 2 раза, 7-10 дней или другие фторхинолоны;
• цефуроксим внутрь 0,5-1 г/сут в 2 приема, 7-10 дней или другие цефалоспорины;
• амоксициллин/клавуланат внутрь по 0,375- 0,625 г через 2-3 раза в сутки 7-10 дней или ампициллин в\м 1,0 г. 4
раза в\м, 7-10 дней.
• Патогенетическая терапия:
• обильное питье-до 2,5-3,0 в сутки;
При высокой лихорадке - нестероидные противовоспалительные
• Десенсибилизирующая терапия, один из нижеперечисленных в течение 3-5 дней:
• цетиризин внутрь по 0,005-0,01 г 1 раз в сутки;
• лоратадин по 0,01 г внутрь 1 раз в сутки.
• Симптоматическая терапия:
при ангинозной форме - полоскание горла дезинфицирующими растворами;
при кожной форме – обработка первичных и вторичных кожных аффектов бриллиантовым зеленым 1%
спиртовым раствором.
• Клинические рекомендации ссылка
180.
ХОЛЕРА181.
ХОЛЕРА – особоопасная карантиннаяболезнь,
вызываемая
Vibrio
cholera,
серогрупп О1 и О139, характеризующаяся
поражением
тонкого
кишечника,
нарушением водно-солевого баланса и
высокой летальностью.
182.
183.
Семейство:МЕДИЦИНСКОЕ ЗНАЧЕНИЕ ИМЕЮТ:
V. CHOLERAE
V. PARAHAEMOLITICUS
V. VULNIFICUS
ВИД:
VIBRIONACAE
РОД:
VIBRIO
VIBRIO CHOLERAE
На основании биохимических и биологических
холерные вибрионы делятся на: два биовара :
КЛАССИЧЕСКИЙ
различий
ЭЛЬ- ТОР
VIBRIO CHOLERAE (биовар ASIATICA)
VIBRIO CHOLERAE (биовар ELTOR)
Холерные вибрионы обладают хорошо выраженной биохимической
активностью по способности утилизировать 3–и сахара (сахарозу,
арабинозу и трегалозу). впервые разделил вибрионы холеры на 6 групп
Хейберг
V. Cholerae принадлежит к 1- й группе по Хейбергу.
184.
МОРФОЛОГИЯ• Холерный вибрион размером 1,5:4,0х0,2:0,4 мкм имеет один
полярно расположенный жгутик. Грамотрицательные, спор не
образуют;
• В мазках из клинического материла и колоний, выросших на
плотных средах наблюдаются типичные вибрионы;
• В висячей или раздавленной капле можно наблюдать подвижность
вибрионов;
• В старых культурах наблюдаются инфолюционные нитевидные,
кокковидные формы;
• Под действием пенициллина образуются фильтрующиеся Lформы.
185.
186.
Культуральные свойстваФакультативный анаэроб. Холерный вибрион неприхотлив к
питательным средам. Хорошо размножается на 1% щелочной (рН
8,6-9,0) пептонной воде, опережая бактерии кишечной группы (среда
обогащения), образует нежную голубоватую пленку и муть. Для
подавления роста протея и некоторых других микроорганизмов
используют пептонную воду с добавлением теллурита калия.
На
плотных
средах
холерный
вибрион
образует
гладкие
стекловидные, прозрачные с голубоватым оттенком дисковидные
колонии вязкой консистенции. Используют щелочной агар, желчно солевой агар, щелочной агар с кровью, наилучшей является TCBS агар (агар с тиосульфатом, цитратом, солями желчных кислот и
сахарозой).
187.
ЭПИДЕМИОЛОГИЯХолера – это острая кишечная инфекция с фекально–
оральным
механизмом
передачи.
Наиболее
распространенный путь передачи – водный, алиментарный,
реже – контактно–бытовой механизм передачи.
Резервуаром инфекции является водная среда. Эпидемии
могут протекать в виде острых вспышек и в виде вялотекущих
эпидемий с постоянно регистрируемой заболеваемостью, но
не с высокой интенсивностью.
Источник инфекции– больной или вибрионоситель. Животные
к возбудителю холеры не чувствительны.
188.
АНТИГЕННАЯ СТРУКТУРАПо структуре:
-О – АГ холерные вибрионы разделены на 150 серогрупп, которые
определятся в реакции агглютинации
-Н – АГ - общие для большой группы вибрионов.
189.
Возбудители классической холеры и холеры Эль –Тор объеденены в серогруппу О1.
Антигены
серогрупп О1 состоят из различных сочетаний
субъединиц А-,В-, С-. Сочетание
-субъединиц АВ- сероваром Огава,
-сочетание АС – серовар Инаба,
-сочетание АВС – серовар Гикошима(Хикоджима).
Вибрионы серогруппы О139 аглютинируются только
сывороткой О139
190.
Холерные вибрионы дифференцируютсятакже при помощи бактериофагов.
V.CHOLERAE лизируются бактериофагами IV группы;
V.CHOLERAE ELTOR лизируется бактериофагами V
группы.
Бактериофаги применяются для диагностики и
профилактики и лечения холеры.
191.
Большая часть вибрионов при попадании вкислую среду желудка погибает и лишь
небольшая
часть
достигает
тонкого
кишечника, где рН среды уже щелочное.
К факторам патогенности, отвечающим за
колонизацию кишечника
относятся пили
адгезии и жгутики .
192.
Факторы патогенности1. Подвижность (жгутики) и хемотаксис.
2.
Ферменты
муциназа
(разжижает
слизь),
нейраминидаза
(взаимодействие с микроворсинками, создание посадочной площадки),
лецитиназа и другие.
3. Эндотоксин - термостабильный липополисахарид, схожий по структуре и
свойствам с другими эндотоксинами грамотрицательных бактерий.
4. Экзотоксин - холероген - главный фактор патогенности, термолабильный
белок.
5. У многих вибрионов, в т.ч. не относящихся к 01 группе, имеются различные
энтеротоксины.
6. Фактор, повышающий проницаемость капилляров.
193.
Фермент муциназа разжижает слизь и облегчает доступвибрионов к слизистой, где щелочной секрет, который
выделяют эпителиальные клетки кишечника, в сочетании с
желчью создают прекрасные условия для размножения
вибрионов
194.
Фермент нейроминидазаобеспечивает
взаимодействие
с
микроворсинками
195.
ВИБРИОНЫэкзотоксины
эндотоксины
экзотоксины
Аналогичные токсинам
эшерихий, шигелл и
сальмонелл
Обеспечивает синтез
Вибриноцидных АТ
Активирует
аденилатциклазу
196.
Клинические проявления зависят от эндо – иэкзотоксинов, которые образуют вибрионы.
Эндотоксин – термостабильный ЛПС, по
строению и активности он схож
с
эндотоксинами прочих грамотрицательных
бактерий.
Он
проявляет
иммуногенные
свойства, обеспечивая синтез вибрионоцидных
АТ, но при этом он играет существенной роли
в формировании клинических проявлений.
197.
Экзотоксин – холероген - термолабильный белок; егообразование кодирует хромосома и плазмидные гены.
Молекула токсина состоит из двух компопонентов: А и Б.
Компонент А в свою очередь состоит из двух субъединиц:
субъединица А1(активный центр) и субъеденица А2,
связывающая компоненты
А и Б , Субъединица А1
активизирует аденилатциклазу , что способствует выходу
жидкости и электролитов из клеток либеркюновых желез в
просвет кишечника.
198.
Токсин не способен реализовыватьдействие в каких либо других клетках.
свое
Вибрионы
серовара
О139
продуцируют
аналогичный токсин, но в меньших количествах.
Кроме того вибрионы способны синтезировать
экзотоксины, аналогичные токсинам эшерихий,
шигелл и сальмонелл.
199.
Холера в просвете тонкогокишечника
200.
КЛИНИЧЕСКИЕ ПРОЯВЛЕНИЯ• Инкубационный период варьирует от нескольких часов до 5 дней
(в среднем 2-3 дня);
• Клинически холера проявляется в виде боли в животе, тенезмы,
рвоты, диареи;
• Тяжелый больной теряет в сутки до 30 л жидкости;
• Стул носит характер «рисового отвара» - бесцветные обильные
испражнения со сладковатым запахом (не фекальный).
• Алгидный синдром – темература тела 34 градуса по Цельсию;
• Осложнениями могут быть: почечная недостаточность, афония,
гипотензия, сердечная недостаточность;
• При неправильном лечение летальность при «холерном алгиде»
достигает 60 %.
201.
МИКРОБИОЛОГИЧЕСКАЯ ДИАГНОСТИКАЦель исследования:
• выявления больных и вибрионосителей;
• установление причины смерти при исследовании
трупов;
• контроль за лечением больных и
санацией
вибрионосителей;
• контроль за объектами окружающей среды и
эффективностью
дезенфекционных
мероприятий.
202.
МАТЕРИАЛ ДЛЯ ИССЛЕДОВАНИЯМатериалом для исследования являются:
испражнения,
рвотные
массы,
желчь,
секционный
материал
(содержимое
желчного пузыря и фрагменты тонкого
кишечника,
смывы
с
постельного
и
нательного белья), вода, или сточные воды,
гидробионты, пищевые продукты.
203.
ПРИВИЛА ПРОВЕДЕНИЯ ИССЛЕДОВАНИЯ- материал в лабораторию доставляют не позднее 2-х
часов после забора(так как возбудитель быстро погибает).
При невозможности быстро доставить образцы для
исследования используют транспортные среды рН 8,2 – 8,6
- емкости для материала нельзя обеззараживать
дезенфектантами, так как даже следовые концентрации
губительно действуют на возбудителя. Все образцы
упаковывают в герметичную тару и спецтранспортом с
курьером доставляют в лабораторию. Протоколы к
исследованию пишут ОБЯЗАТЕЛЬНО КАРАНДАШОМ.
204.
Культура Vibrio cholera на TCBS-агаре(Thiosulfate-citrate-bile-salts-sucrose agar –
тиосульфат-цитрат-желчь-соль-сахароза
агар)
205.
УСКОРЕННАЯ ДИАГНОСТИКА- для ускорениия диагностики холеры применяют
иммунолюминисцентный и иммобилизационный
методы, РПГА с диагностикумом.
- при выделении VIBRIO CHOLERAE
группы
отличной
от
О1,
возбудитель
необходимо
типировать с помощью других сывороток.
- определение АТ в крови больных носит
вспомогательный характер. Их выделяют РА, а так
же путем обнаружения вибрионоцидных АТ и
антитоксинов.
206.
СПЕЦИФИЧЕСКАЯ ПРОФИЛАКТИКАРазработана убитая вакцина из штаммов Огава и
Инаба, холероген–анатоксин для подкожного
введения и бивалентная вакцина из анатоксина и
О-Аг Огава и Инаба.
Эффективность
от
применения
вакцинных
препаратов
составляет
60
–
70%,
невосприимчивость сохраняется 3-6 месяцев,
поэтому
вакцины применяются только по
эпидемиологическим показаниям.
207.
НЕСПЕЦИФИЧЕСКАЯ ПРОФИЛАКТИКА• Мероприятия, направленные на разрыв путей передачи
(предупреждение заноса инфекции на территорию
страны,
санитарно-просветительная
работа
с
населением,
обеспечение
населения
доброкачественной питьевой водой, канализацией,
пищевыми продуктами, дезинфекцией и т.п.);
• Важно
обеспечение
населения
современной
полноценной
медицинской
помощью
(выявление,
диагностика, госпитализация, Лечение, карантин.
208.
ЛЕЧЕНИЕЛечение холеры проводится в двух направлениях:
А)Регидратация ( восполнение потерь жидкости и
электролитов введением изотонических, апирогенных
солевых
растворов,
а
также
плазмозаменяющих
жидкостей внутривенно или per os);
Б)
Антибактериальная
терапия
(
хлорамфеникол, а также фторхинолоны)
тетрациклины,
209.
Основными принципами терапии больныххолерой являются:
• Возмещение потери жидкости и
восстановление электролитного состава
организма;
• воздействие на возбудитель;
• лечение начинать в первые часы от начала
болезни.
Оральная регидратация (при дегидратации I-II
степени и отсутствии рвоты):
регидрон, глюкосолан, цитроглюкосолан, - 2
литрами регидратационной жидкости
в течение первых 24 часов.
Парентеральная регидратационная терапия
кристалоидными растворами:
хлосоль, ацесоль, трисоль. Проводится в два этапа,
длительность I этапа – до 3 ч,
II этапа – по показаниям до нескольких суток (при
отсутствии рвоты возможен
переход на пероральный прием жидкости).
Антибиотикотерапия представлена в таблице.
Клинические рекомендации
210.
V. parahaemolyticus (парагемолитический вибрион) являетсягалофилом, встречается в морской воде Японского, Черного,
Каспийского и других южных морей. При употреблении морских
продуктов, не подвергнутых достаточной термической обработке,
этот возбудитель вызывает у людей пищевые токсикоинфекции и
дизентерия - подобные заболевания. Вызывает гемолиз на
кровяном агаре с повышенной концентрацией хлористого натрия
(на 7% NaCl - штаммы с энтеропатогенными свойствами).
V. vulnificus - наиболее патогенный вид для человека из
нехолерных вибрионов. Выявляют в морской воде и ее обитателях.
Вызывает раневые инфекции, септицемии и другие заболевания.
Ферментирует сахарозу и лактозу, на TCBS - агаре образует
желтые колонии.
211.
КАМПИЛОБАКТРИИ212.
КАМПИЛОБАКТЕРИОЗ• Кампилобактериоз – это острое инфекционное антропонозное
(зоонозное) заболевание, характеризующееся синдромом
общей интоксикации, поражением ЖКТ и возможностью
генерализации у маленьких детей (1 года жизни) и ослабленных
детей в виде септического процесса.
• Нередко капмилобактериоз маскируется под термином «диарея
путешественников».
213.
КЛАССИФИКАЦИЯ• Семейство Spirillaceae ;
• Род Campylobacter ;
• Известно более 10 видов возбудителя, из них наибольшее
значение в патологии человека имеют C. jejuni, C. fetus,
C.coli.
214.
МОРФОЛОГИЯ И КУЛЬТУРАЛЬНЫЕСВОЙСТВА
• Кампилобактеры – грамотрицательные извитые
бактерии длиной 0,5-5 мкм и толщиной 0,2-0,5 мкм,
имеющие характерную форму запятой или S образную
форму;
• В мазках из патологического материала часто
располагаются попарно в виде «летящей чайки»;
• При старении культуры переходят в кокковидную форму;
• Подвижные, имеют один концевой жгутик;
• Капсулы и споры не образуют;
• Микроаэро- и капнофилы.
215.
216.
ЭПИДЕМИОЛОГИЯ• Зооантропоноз;
• Важнейший источник инфекции- сельскохозяйственные животные
и домашние птицы, редко человек;
• Кампилобактериоз распространен повсеместно и составляет 514 % всех диареегенных заболеваний;
• Механизм передачи – фекально-оральный (путь – алиментарный,
водный), контактно-бытовой ( путь контактный прямой и непрямой);
• Естественная восприимчивость людей высокая;
• Случаи заболевания регистрируются в течение всего года, чаще в
летне-осенние месяцы.
217.
АНТИГЕННАЯ СТРУКТУРА• Имеют О- и Н- антигены, по которым
подразделяются на 60 сероваров.
• Обладают плазмидами, с которыми
связана антибиотикоустойчивость.
218.
ФАКТОРЫ ПАТОГЕННОСТИ• Эндотоксин, который связан с ЛПС;
Некоторые штаммы продуцируют :
• Холероподобный энтеротоксин;
• Цитотоксин.
219.
ПАТОГЕНЕЗ И КЛИНИКА• У человека кампилобактерии вызывают 4 группы
заболеваний:
• 1)диареи (энтероколиты), генерализованные (сепсис);
• 2)локальные внекишечные (менингиты, энцефалиты,
эндокардиты);
• 3) ГВЗ новорожденных;
• 4)Заболевания ротовой полости.
220.
• Гастроэнтерит возникает в результате действияэнтеро- и цитотоксина, выделяемых некоторыми
штаммами бактерий, размножающихся в ЖКТ;
• Инкубационный период составляет 2-3 дня;
• Болезнь начинается остро, с диспептических
расстройств (диарея, рвота), интоксикации,
повышения температуры;
• Длится около 10 суток.
221.
ЛАБОРАТОРНАЯ ДИАГНОСТИКА-Бактериологический метод
• Основан на выделении чистой культуры возбудителя из
испражнений, рвотных масс, промывных вод из желудка посевом
на кровяной или эритритный агар с железо-сульфитнопируватными добавками;
• Для видовой дифференцировки культивируют при различных
температурных режимах;
• В мазках из фекалий определяют типичные по форме микробы в
виде «летящей ласточки».
-Для серологической диагностики используют РИФ, РА, РПГА, РСК.
-Экспресс диагностика- постановка РИФ со специфическими
люминесцентными сыворотками.
222.
КУЛЬТУРА CAMPYLOBACTER.223.
ПРОФИЛАКТИКА И ЛЕЧЕНИЕПрофилактика
• Специфическая профилактика не разработана;
• Неспецифическая
профилактика
заключается
в
проведении противо-эпидемических мероприятиях, как
при сальмонеллезах.
224.
Лечение• Выбор метода лечения кампилобактериозом зависит от клинической
картины, типа диареи, степени проявлений симптомов.
• Этиотропное лечение: рекомендованы макролиды при инвазивном типе
диареи в первые дни болезни. Используются азитромицин**,
кларитромицин. Кроме этого, может быть использован доксициклин** у лиц
старше 8-ми лет. Эффективность аминогликозидов, хлорамамфеникола
ниже чем макролидов. Резервными препаратами для лечения
генерализованных форм кампилобактериоза, резистентных к проводимой
терапии, являются карбапенемы и комбинированные с ингибиторами bлактамаз пенициллины. Продолжительность этиотропной терапии зависит
от формы заболевания. При локализованных формах она составляет 35 дней, при генерализованной — не менее 14 дней.
• Рекомендовано использовать пробиотики при кампилобактериозе
225.
ЛечениеПатогенетическая терапия.
Рекомендована:
• регидратация, включая оральную регидратацию и инфузионную терапию
(Рекомендовано при наличии симптомов дегидратации 1 и 1-2 ст.
проводить оральную регидратацию с использованием глюкозо-солевых
растворов);
• сорбенты (рекомендовано использовать энтеросорбенты.
Диоктаэдрический смектит** может быть использован в терапии
кампилобактериоза; другие энтеросорбенты не рекомендуются в терапии
кампилобактериоза).
• пробиотики;
• ферменты.
Клинические рекомендации

medicine
medicine








